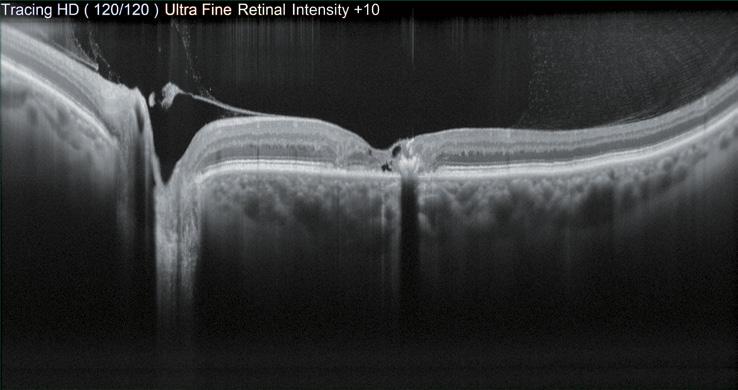

ESCRS’s vision is to educate and help our peers excel in our field. Together, we are driving the field of ophthalmology forward.

Publisher Carol Fitzpatrick
Executive Editor
Colin Kerr
Editors
Sean Henahan
Paul McGinn
Managing Editor
Caroline Brick
Content Editor
Aidan Hanratty
Senior Designer
Lara Fitzgibbon
Designer
Ria Pollock
Circulation Manager
Angela Morrissey
Contributing Editors

Howard Larkin
Dermot McGrath
Roibeard Ó hÉineacháin
Contributors
Maryalicia Post
Leigh Spielberg
Gearóid Tuohy
Priscilla Lynch
Soosan Jacob
Colour and Print
W&G Baird Printers
Advertising Sales
Amy Bartlett
ESCRS
Tel: 353 1 209 1100
email: amy.bartlett@escrs.org

Published by the European Society of Cataract and Refractive Surgeons, Temple House, Temple Road, Blackrock, Co Dublin, Ireland. No part of this publication may be reproduced without the permission of the managing editor.
Letters to the editor and other unsolicited contributions are assumed intended for this publication and are subject to editorial review and acceptance.
ESCRS EuroTimes is not responsible for statements made by any contributor. These contributions are presented for review and comment and not as a statement on the standard of care. Although all advertising material is expected to conform to ethical medical standards, acceptance does not imply endorsement by ESCRS EuroTimes. ISSN 1393-8983

CORNEA
COVID-19
26 Corneal restoration using stem cell therapy
28 Prompt diagnosis and treatment key in neurotrophic keratopathy
29 Nanoparticle technology shows promise in vision correction
RETINA
30 Vitreoretinal surgery still key in treatment of severe AMD
31 Effective techniques for vitreomacular traction
33 Ophthalmologica highlights
34 Bringing intravitreal injections into the home during a pandemic
35 Axial elongation and myopic macular degeneration
GLAUCOMA
PRESBYOPIA
P.8 & correcting IOLs: Key clinical opinions & practice patterns
As certified by ABC, the EuroTimes average net circulation for the 10 issues distributed between February and December 2019 was 47,863 EUROTIMES | JULY/AUGUST 2020
Astigmatism
As Chairman of the ESCRS Young Ophthalmologists Committee, I have observed with great pride over the past few months the courage that our YOs have shown in fighting the COVID-19 pandemic.
I am very pleased to see that some of these YOs have contributed to this issue of EuroTimes, which has a special focus on Young Ophthalmologists.
When elective ophthalmological procedures were shut down in our clinics in the early months of the pandemic, YOs were called on to join the frontline teams treating patients who had contracted the virus.
Some junior residents were retrained to work in emergency departments, and others were given responsibilities that would have taken them outside of their comfort zones as trainee ophthalmologists.
As we begin to return to “normal” work, our YOs will face many challenges in the months ahead. They will have to relearn some of the surgical skills they had been perfecting as opthalmologists starting out in their careers. They will also have to resume their studies as they prepare to sit examinations that will decide their future career paths.
There has been a lot of talk about the New Normal, but we may be surprised how quickly we return to our old patterns of living and working. Of course, we cannot forget the continuing threat of COVID-19, but we must hope that a vaccine will be found to treat the virus and to reduce its threat to society.
As my friend and colleague, Professsor Rudy Nuijts, President of the ESCRS, has pointed out, one regrettable casualty of the COVID-19 crisis is the 2020 live ESCRS Congress, which was to be held in Amsterdam in October. Instead, we will host our first ESCRS Virtual Congress on Friday 2 October through Sunday 4 October.
Noel Alpins (Australia), Bekir Aslan (Turkey), Roberto Bellucci (Italy), Hiroko Bissen-Miyajima (Japan), John Chang (China), Béatrice Cochener-Lamard (France), Oliver Findl (Austria), Nino Hirnschall (Austria), Soosan Jacob (India), Vikentia Katsanevaki (Greece), Daniel Kook (Germany), Boris Malyugin (Russia), Marguerite McDonald (USA), Cyres Mehta (India), Sorcha Ní Dhubhghaill (Ireland)
Rudy Nuijts (The Netherlands), Leigh Spielberg (The Netherlands), Sathish Srinivasan (UK), Robert Stegmann (South Africa), Ulf Stenevi (Sweden), Marie-José Tassignon (Belgium), Manfred Tetz (Germany), Carlo Enrico Traverso (Italy)
The good news is that our face-to-face meeting will be replaced by a Virtual Meeting, which will include the Young Ophthalmologists Programme. The ESCRS Programme committee has been very busy preparing for the meeting and we can look forward to virtual presentations featuring world-class research in an interactive setting. Watch for more details about the meeting in EuroTimes and at www.escrs.org and I look forward to meeting you “virtually” in a few months’ time when we will take the opportunity to renew old friendships and make new friends in our ever-expanding ESCRS family.
Stay
 Professor Oliver Findl is Chairperson of the Young Ophthalmologists Programme and Secretary of the ESCRS
Professor Oliver Findl is Chairperson of the Young Ophthalmologists Programme and Secretary of the ESCRS





The good news is that our face-toface meeting will be replaced by a Virtual Meeting, which will include the Young Ophthalmologists Programme



Early interactions can leave a lasting impact on a medical career. So what makes a good supervisor?
Luke Sansom FRCOphth reports
Many doctors will tell you that their years as a trainee were the best of their medical careers. A time when new skills, knowledge and techniques are learnt on a near daily basis. Enthusiasm is at its peak. A time when frequent mistakes will be made, but important lessons learnt. The opportunity to cut one’s teeth in preparation for the years of consultant life that lie ahead.
These years do of course come with their challenges. Trainees are often thrust into an environment littered with unfamiliar equipment, new jargon and clinical uncertainty; there are the inevitable surgical mistakes and errors in clinical judgement. Not to mention the stresses and strains of frequent upheaval and the impact of busy work schedules on family and social life.
Trainees are not alone in this process though, they are surrounded by trainers, supervisors and mentors. Most trainees will tell you of their experiences of the good, the bad and the ugly of supervision, but what is it that makes a good supervisor?


Understanding: “The most crucial time I spend with a new trainee is the first hour, if you get it right, this is the ticket to a

successful relationship.” The words of a vastly experienced colleague. He explains to me that when meeting trainees for the first time, rather than dredging through the monotonous formalities of supervisor forms and reviewing surgical logbooks, he turns his computer off and simply says “so tell me about you”. His reasoning, as he explains, seems sound. He wants to know “what makes them tick”; where do they live, how do they get to work, where do their partners live, do they have kids, how was their last job (off the record) and everything else in-between.
By seeing a trainee as a person with a whole life that exists beyond the workplace supervisors may be better placed to anticipate problems and understand issues along the way.
Willingness: “You are taught for many years how to be a good clinician; you don’t get five minutes being told how to be a supervisor.” The skills needed to succeed in supervision are not necessarily formally taught and may not come naturally to some. Trainers, like trainees, will make mistakes, but this is part of the process. Supervisors I’ve spoken to have advocated talking to their colleagues, conducting regular appraisal, taking feedback from trainees and even formal courses to help prepare for, and develop, in this role.
I would not say I see a clear correlation between those whom I consider to be excellent clinicians and surgeons and those who I consider to be excellent supervisors. I have met many good surgeons who seem incapable of explaining how they do what they do or understanding why others are unable to grasp it. Talented? No doubt. Great supervisors and educators? Not so much. Humility: So, what makes great supervisors different? Is it that good supervisors are just more self-aware and able to identify their strengths as well as their deficiencies? Possibly. To recognise that one does not necessarily possess all of the knowledge, skills and expertise required to meet the needs of a trainee at all times is a true skill indeed. It is admittedly more subtle and hidden than the surgical skills needed to perfectly suture a corneal graft, but it is certainly no less of a skill to have. “I’m not sure how to help” is relatively easy to say, but to follow this with “but I’ll find someone who does” is a necessary trait for good supervision. It is of course reasonable not to know all the answers; sometimes being a sounding board is all that is needed. It may indeed at times be best not to tell trainees all the answers you know. Knowing when to stimulate discussion, play the devil’s advocate, and construct and develop
thoughts and plans together plays a key role in developing trainees.
Vulnerability: A colleague quite openly talks about her struggles through medical training. As she openly explains to her trainees, it’s okay to be vulnerable, and it’s okay not to cope at times. By sharing her own experiences and being open about her own vulnerabilities she says she hopes this allows her trainees to start a conversation about their own concerns and issues early before problems spill over. I suspect many of us would find it hard to be so open and honest, but the potential benefits for both parties are clear to see.
Adaptability: What is required of a trainer may well change over time. Speaking to colleagues regarding the early years of training, the character traits that were most admired were of someone who exuded confidence and provided calming reassurance. It is easy to understand why when, as one colleague put it, “I was petrified every time I went to work that I was going to blind someone”. To watch a tentative, quivering, cack-handed junior take a blade to the eye of a patient and not show your anxiety must take a whole new level of confidence and calm indeed.
Trainees towards the end of their training no longer yearn for a calming presence beside them; they instead appear to look to their supervisors increasingly for mentorship, as a role model and to help guide them through the transition between trainee and consultant.
So how can trainers be all things to all men? Is there a one-size-fits-all? Probably not. All trainees have their preference, a supervision style that some may find empowering, exhilarating and the freedom to push the limits their competence, may make others uncomfortable, nervous and resistant. As supervisors, just as with our patients, we must explore the ideas, concerns and expectations of trainees to facilitate tailored, bespoke and targeted supervision to maximise the trainee experience.
The little things: Good supervision isn’t all about tackling the big career events or the difficult conversations. Like in many walks of life, sometimes it’s the little things that count and this may well be a good starting point for anyone embarking in their role as a supervisor.
Good supervision can be as simple as encouraging a trainee to have a regular cup of coffee. After all, as we all know, a thirsty and caffeine-depleted surgeon is not a pretty sight. Remind them to take a lunch break. Show them where to put their coat on the first day. Introduce them to the friendliest and most welcoming of the clinic nurses, and warn them who the grumpy ones are – “it’s not just you, he’s like that with everyone”. Simple things, but collectively hugely powerful.
A trainee who feels comfortable in their environment will be more willing to ask questions, positively contribute to departmental development, flag up safety issues and reflect back a positive and
supportive demeanour. Ultimately, all of which will improve patient experience and safety, which is always our primary objective.
The supervisors who did not volunteer for their role can sometimes be painstakingly obvious to those unfortunate souls that are assigned to them. Rushed meetings at the end of clinical, slow or non-existent email replies. It is important that healthcare organisations engage with clinicians to improve participation in supervision through education and training. A poorly prepared and reluctant supervisor will only breed unhappiness for both trainees and themselves alike, which is of no benefit to anyone. Some clinicians and supervisors do feel trainees are too protected, mollycoddled and hence too cautious and lacking sufficient exposure. Phrases like “it’s not like it was when I was a registrar” can on occasion be heard rattling around the consultant office corridor. Things have certainly changed in medical education and training over the past few decades, and on a whole, many would say for the better. But is there value in a hands-off, sink-orswim approach? Or is this ‘freedom’ merely providing trainees with just enough rope to hang themselves? Speaking to colleagues there were some who did indeed like the challenge of being “dropped in at the deep end”, but it’s fair to say there were many who did not. On the whole though, it seems that the advocates of “the best supervision is less supervision” approach are probably going the way of the dinosaurs.
Supervisors are only half of the equation. The trainee is key to the whole process. So, what makes a good trainee? What do supervisors expect? Speaking to my supervisors, the message is clear. They want ‘trainable trainees’. Someone who does the basic things right and has a positive attitude. Reliable, hardworking, willing to learn and a self-awareness of their limitations are phrases I heard time and again.
There is an amusing anecdote of a firstyear resident some years before my time walking into the theatre of arguably the best cataract surgeons in the region and declaring “by the end of this year I’ll be a better surgeon than you”. Needless to say, they didn’t last long. As good as a supervisor and trainer may be, trainees must bring their own key set of skills and attitudes to make this relationship work.
Trainees too often provide unofficial peer supervision and mentorship of their more junior colleagues. I can recall my first year in ophthalmology training and the support, guidance and encouragement shown to me by the senior registrars; still junior enough to remember being new but senior enough to offer advice, guidance and encouragement. Research supervision: Many trainees wish to get involved in research, either through their own interest or as a requirement of their
training programmes. One senior academic I spoke to explained that much of her role is to help show trainees how involvement in research will help inform their decisions and increase their confidence in exploring their own ideas and questions.
Academic supervision is often about gently guiding a journey through a project from conception and design, through to fruition. For me, my journey through academia, guided by an outstanding team, was an unparalleled time of learning and personal development.
Some top tips from a senior academic for those wishing to embark on research were to have a clear and focused question or risk being overwhelmed. Ask early and often – most problems can be overcome if tackled early. Start writing early, blank paper can be intimidating; anything, even if rubbish, is better than nothing it all. Don’t take reviews too personally!
The world is a strange place for us all at the moment. The post-COVID-19 era will certainly be different. We must be proactive and innovative in how we work and train, the role of the trainer and mentor may be more important now than ever before.
I suspect we will see increasing use of long-distance learning via video conferencing, e-learning modules and simulation. It may be that for many trainees their first ‘capsulorrhexis’ will be performed on a grape sat at their dining table, or their first ‘trabeculectomy’ on an apple in their back garden whilst watching YouTube!
The risk of accepting that less can be taught and therefore less is learnt is certainly real but from my own experience of the enthusiasm, creativity and resilience shown by my own trainee colleague, trainers, mentors and educators the possibility of ascending to an even higher level of excellence in our ability to train and educate is the much more likely outcome.
Supervisors, like the trainees they oversee, come in all shapes and sizes. Each with their own experiences, their own lessons learnt and their own ideas. Some will take to it more naturally whilst others may have to work at it over time. However, from my own experiences I can say that each trainer, educator and supervisor I have had has added value to my career. A piece of advice. An observation or opinion. An ear to listen to my concerns. We all have something to offer our trainees and colleagues. Being a supervisor is a journey of constant development, learning and improvement but a journey that all of us should take because the effort put in will most certainly pay huge dividends for all parties involved.
Dr Sansom is a Specialty Trainee at the York Teaching Hospital NHS Foundation Trust, Yorkshire, UK, and was the winner of the 2019 John Henahan Prize
It almost goes without saying that proper training is essential for producing good doctors. But how do those doing the training learn that particular craft?
Speaking at the 23rd Winter Meeting of the ESCRS in Marrakech, Morocco, Larry Benjamin MB BS, FRCS, FRCOphth, DO, Consultant Ophthalmologist at Stoke Mandeville Hospital, Buckinghamshire, UK, described an older form of training: “We used to do the old “see one, do one, teach one” – you’d expect a good surgeon to just watch something and then pick it up and be able to do it themselves.”

This was never appropriate and is no longer good enough. Nowadays, things are more structured, with greater support for teacher and trainee.
There are other reasons why a more structured approach is necessary. A 2004 BMJ article laid out the ways in which training time had decreased in the UK, between the European Working Time Directive and the UK’s own “Calmanisation”, a name given to the reforms brought in by Sir Kenneth Calman in the mid-90s. These meant that a training period for a general surgeon, of roughly 30,000 hours between becoming a senior house officer and getting a consultant post, was reduced to 6,000 hours. How to cram in the best training in that time?
In a study that examined surgeons at various points of their career carrying out a cataract operation and scored them using a task-specific grading process, it was demonstrated that there is a ceiling of experience. For surgeons who had performed fewer than 50 operations, they scored within a certain window. The spread was greatest for surgeons who had performed between 50 and 250 operations. The scores of those who had performed between 250 and 500 and those who had performed more than 500 operations were again significantly different, but above 500 cases there was no significant difference.. “This evidence [shows] that people can be seen to improve with numbers as well as with time,” Dr Benjamin said.
As well as the more general banner of “experience”, the UK also has 183 competencies that trainees must achieve by various methods, which requires more work for the trainers. This involves meeting with trainees, discussing past cases and so forth. This means that: “Now we accredit people because they are competent, rather
than just because they’ve done five or six years of training,” Dr Benjamin added.
The Royal College of Ophthalmology in the UK runs a three-day course in teacher training (Training the Trainers). This includes sections on adult learning theory, which asks how adults learn, what motivates them. “If you can write aims and objectives about a teaching session it very much structures it in your mind,” Dr Benjamin adds. It also gives the students an overview of the content of the teaching session.
There is also the four-step technique, which breaks down any practical procedure into four stages: Demonstration, Deconstruction, Comprehension and Execution.
Another thing for trainers to consider is constructive feedback. “It’s very useful to learn what you’ve done right and what you might do differently, we don’t call it what we’ve done wrong, we call it what you might do differently in the future, and try and keep it as constructive as possible,” Dr Benjamin said.
There are a variety of teaching techniques that can be employed. The traditional lecture may be a good way
of giving out a lot of information to a lot of people, but retention of that information is poor. Small group teaching and brainstorming sessions can be more effective, as well as a technique entitled “Set, dialogue and closure”.
“The dialogue is telling them the story and then the closure is summing up,” Dr Benjamin explains. “The Americans call this tell them what you’re going to tell them, tell them, and then tell them what you’ve told them. It’s important to have that kind of structure, so people remember things.”
He cites the pyramid of learning, which at its base has knowledge, then moves upwards through comprehension, application, analysis, judgment and finally evaluation. “You’ve got to know what it is you’re talking about,” explains Dr Benjamin. “You’ve got to understand how to use that knowledge, how do you apply that knowledge and comprehension to say phaco surgery – you know the phaco probe oscillates 40,000 per second and it’s got a fluid sleeve around it to cool it, but how do you apply that in the operating theatre?”
Beyond the Royal College of Ophthalmologists three-day course in Training the Trainers, Dr Benjamin recommends a book by Irish general surgeon Rodney Peyton entitled Teaching and Learning in Medical Practice. Of course, for those who are really determined to improve their own standards of teaching, there is the possibility of a Master’s in Medical Education.
“All these other things make your training for your trainee, a much more rewarding affair,” he concluded.
Larry Benjamin: larry.benjamin@btopenworld.comin
We used to do the old “see one, do one, teach one” – you’d expect a good surgeon to just watch something and then pick it up and be able to do it themselves
Larry Benjamin MB BS, FRCS, FRCOphth, DO
You’ve got to know what it is you’re talking about. You’ve got to understand how to use that knowledge, how do you apply that knowledge and comprehension...
Larry Benjamin MB BS, FRCS, FRCOphth, DO

The Faros surgical platform enables cataract, vitrectomy and glaucoma surgery of the highest level while constantly remaining comfortable and intuitively operable. The reliable flow control makes the surgeon’s work even easier and safer than before. In addition, the Faros impresses with versatility, innovative technologies, exceptional functionality and ease of use.
→ Available as an anterior platform or as a combined anterior/posterior platform
→ Cutting-edge dual-pump system with flow and vacuum control with its unique SPEEP Mode™
→ Proven easyPhaco® technology
→ Continuous Flow Cutter for traction-free vitreous body removal
Make the difference – with the new Faros: www.oertli-instruments.com


Last week was tough. Another journal turned down my manuscript.
One that I spent months on perfecting, revision after revision. One that I had hopes for after a long hiatus. I am a cornea surgeon-turned-junior academic. The start of my new career coincided with the peak of the COVID19 pandemic, when clinics were closed, surgeries cancelled, labs shut and fieldwork suspended.
It was the first time, for me as a clinician, to establish an alternative workplace at home. I found there are different levels to working from home. Sir Isaac Newton set a historically high bar. Quarantined when the plague swept Europe, he managed to produce landmark papers preceding modern calculus and theories of optics, and, on the grounds of his family estate, saw the apple tree that changed the world. Then there are mere mortals who cash in on the newfound latitude, saving a good deal of time from mundane commute, meaningless meetings and sometimes awkward watercooler chit-chats. Then there are parents. And there are parents who have young children around all the time.
My husband and I are such an example. We have two children aged 11 months and 4 years. Closure of school and daycare meant that the delicate boundary between work, school and family life was undone overnight. Every day we woke up to make sure our boys were fed and intact, and to keep them out of mischief in the house. Young children are naturally inquisitive and curious, especially about tasks on your computer and things you say no to. They also crave parental company and always come up with random requests to be close to you. Their wishful little eyes see through your enduring guilt as a working parent, making it almost impossible to decline. Late night and before daybreak, in reality, are the only time for a protected home office, when my tiny new coworkers are asleep.
Since the pandemic put a stop to all schools in Hong Kong in January, I was
On the other hand, this crisis might rise as an opportunity for those with fewer family duties to thrive. While extension of contracts and funding may mitigate the disparity due to COVID-19, a more accommodating and family-friendly culture in the academic community will truly make a difference in the long run.
granted a train of slashes – clinician/ junior academic/ crisis manager/ sanitation monitor/ homeschool teacher/ entertainment curator/ lunch caterer/ curriculum coordinator. My desktop was covered in yellow sticky notes of reminders and task lists. My mind was constantly consumed with plans and schedules to make sure everyone in the house was well taken care of. Busywork is not only draining, but also intrinsically incompatible with academic research, in which headspace and quietness are pivotal. Too much multitasking reduces one’s ability to focus. Too little time is left for thinking and writing scientific papers.
Traditionally, women have been the one to take on more household labour and child-rearing duties. They were disproportionately affected by the sharp increase in responsibilities mirroring the curve of coronavirus. Recent studies have shown evidence that, across disciplines, since the lockdowns began, female researchers were falling behind their male counterparts, posting fewer preprints and starting fewer new projects. The real effect will surface in the next few years as it takes time for peer review and for new projects to complete.
In academia, a researcher’s number of key authorships in high-impact scientific journals and the ability to secure major funding for research work are the most important metrics for performance and determinants for career advancement. In plain English, papers and grants are the key. This system works in such a way that researchers with a longer track record are in a stronger position to win competitive grants, which in turn support more research output. This cycle propagates. For early-career academics, a period of loss in productivity means a loss in the opportunity to build the credentials they need to move up the academic ladder. Success at publication and funding is unpredictable and rejection is common. They may or may not be able to make up for the loss against the ticking tenure clock.
Early life in academia is a humbling experience. It is part rewarding and part challenging, especially in this extraordinary time of a century. Holding a baby in one hand and having a preschooler on the other while re-submitting a paper is distracting to say the least, but at the same time, surprisingly comforting and encouraging. We know that we are very lucky to have the job and the health we have now. The daily challenges we face are very real and can be overwhelming at times. Yet, like everything in life, this too shall pass.
Just keep going. Keep writing. Keep submitting.
Dr Allie Lee is Clinical Assistant Professor, Department of Ophthalmology, LKS Faculty of Medicine, University of Hong Kong
Ophthalmology residents appear to be among the specialists most at risk for clinical exposure to SARSCoV-2, a survey conducted during the worst days of New York City outbreak suggests. Experience gained should help prepare for the next wave. Inadequate availability of personal protection equipment (PPE) and testing compounded the problems.
New York quickly became the epicentre of the coronavirus pandemic in the US (and the world) in April. Starting with one positive case on March 1, a health care worker returning from Iran, the infection spread to more than 200,000 people by April 21, with more than 21,000 deaths.
Royce Chen MD and colleagues surveyed residency programs throughout the five boroughs of New York City to investigate the effect of the pandemic. The survey was conducted in April and included responses from 2,306 residents participating in 340 residency programmes representing 24 specialty categories. Twelve ophthalmology programmes were included in the survey.
The survey gathered information on three distinct groups: confirmed cases where residents had COVID-19 symptoms and positive test results; presumed cases where residents had symptoms but no test results, and suspected cases where symptoms were present, but tests were negative.
Some 45.1% of programs reported at least one resident with confirmed COVID-19, with 101 resident physicians with positive SARS-CoV-2 test results, with another 163 residents presumed positive for COVID-19 based on symptoms. Dr Chen was among those who tested positive for the virus.
Residents developed COVID-19 symptoms very early in the outbreak. Two SARS-CoV-2 positive residents were hospitalised, with one in intensive care. As masking practices improved - both for physicians and for patients, the numbers of new cases started to drop.
The study took a closer look at specialties with at least 100 survey respondents. Interestingly, ophthalmology residents were among the highest risk groups, exceeded only by anaesthesiologists and emergency medicine residents.
This is most likely attributable to close proximity to patients during eye exams and inadequate use of personal protection equipment (PPE) in the early days of the outbreak, according to Dr Chen, a retina specialist at Columbia University Irving Medical Centre. She also directs the ophthalmology residency programme there.
“This list is not definitive, as the study did not have complete representation from every specialty. It is still possible and even likely that specialties like ENT/Dentistry – that are also more highly exposed to aerosols and respiratory secretions are high risk as well and could be shown in future serology studies,” she cautioned.
The survey highlighted several important issues related to the overall pandemic response. Slightly more than half of the residency programmes reported that residents were waiting for, or were unable to obtain, SARS-CoV-2 testing. Moreover, false negatives associated with PCR testing may have also contributed to an underestimation of cases.
The study also showed shortcoming with the quarantine process. Most programmes, 80%, reported it was necessary to quarantine a resident. However, 15 virus-positive patients and another 26
presumed cases did not quarantine. Possible explanations include lack of symptoms, work force needs, and delayed testing.
Half of programme directors surveyed said their residents had had to work with suboptimal PPE. Residents reported reusing or extending the use of what were considered single-use masks with many reporting that personal protective equipment was suboptimal. The situation has improved since the study was conducted, Dr Chen told EuroTimes
“The PPE situation has improved a lot. I think most hospitals have significantly improved supplies of surgical masks, but certainly physicians are still reusing/extended using N95 masks. Life has changed completely from the days where we used a mask once and then discarded it. I don’t know if we’ll ever return to that state, at least during this pandemic, but on the flip side, even with our current practices where we are still practising extended use and reuse of masks, our infections rates have dropped a lot.”
Dr Chen advised that all residents need to use at least surgical masks at all times, and their patients need to be surgical masked at well. Masks on patients should not be removed for procedures. The slit lamp shields probably also offer a good layer of added protection for ophthalmologists. Full PPE (including N95 and eye covering) should still be employed for COVID-19 positive patients or persons under investigation, she emphasised.
“I think ophthalmology residents should take PPE seriously, but they should also take some comfort in the fact that new cases dropped with more availability of PPE and widespread protocols mandating masks for both physicians and patients. We need to feel that we are providing care safely – both for ourselves and for our patients – I think that with adequate infection control practices as mentioned above, and continued masking of health care workers and patients, we are providing care safely. “
Dr Chen said he was somewhat reassured that most of those residents who did become infected did not get very sick. However, as the prospect of subsequent waves of coronavirus infection looms, it is essential to maintain vigilance, maintain protocols and keep adequate supplies of PPE.
The full report of the New York City Residency Program Directors COVID-19 Research Group is available via medRxiv at https://bit.ly/ET-NYC-COVID

The Coronavirus pandemic hit Morocco in early March, I clearly remember the first cases being announced, schools and public places closing up as well as borders, all in the span of a week or less. The lockdown announcement and necessary measures were taken in record time as soon as the first cases appeared.
The country has been dealing with the crisis in an impressively efficient way. Although no one had been through a similar thing before, rapid and wise decision-making that was daily communicated to the nation played a big role in controlling the situation and holding the citizens accountable. The mortality rate on the day I am writing this is around 2%.
As for healthcare, the Ministry of Health deployed outstanding means. In few days only, new facilities were available, hospitals were deployed to receive and take care of COVID-19 patients, various departments, other than infectious diseases, completely switched their settings and activities over night to help control the situation.
And in the midst of this wave, young ophthalmologists played a big role on various levels.
As some fellow residents in different specialties, many ophthalmology residents were assigned to COVID-19 departments full time. After refreshing their ICU training and working along other colleagues, many found themselves making admissions and triage, swab tests, follow-up of patients, care in ICU units…

Certain ophthalmology departments across the country were fully transformed into COVID-19 units, either for isolation, monitoring or life support. In the span of only a few days, many ophthalmologists had to wear different caps to take care of patients with a scope of diseases and symptoms that have absolutely nothing to do with their field of expertise, that is the eye.
The Moroccan Society of Ophthalmology guidelines and support were crucial in setting a unified plan to tackle the new situation as ophthalmologists. It directed towards postponing all elective procedures and non-urgent clinics, and maintaining emergency consultations and surgeries.
Young ophthalmologists, both specialists and those in training, were the main providers of all available eye care in the kingdom for a while. Certain ophthalmology departments kept an in-patient activity solely for management of life and sightthreatening emergency cases and surgeries, which was the case in my current department. We kept a daily virtual log with our head of department and the professors, where we discussed emergency cases together and sought guidance for uncertain situations.
The particularity of certain cases was tricky on non-medical levels, I would mention the specific cases of paediatric patients coming from remote regions, and the delicate details regarding companions, and the benefit vs risk balance of in-hospital care in the midst of a pandemic. This virtual mentoring was really helpful, for those reporting duty on the spot, and for those staying at home.
However, like all trainees around the world, young ophthalmologists were faced by many personal challenges depending on where they are in their careers. Residency trainings in the hospital were suspended for a while, and this affected the youngest in a different way than it affected the senior residents. For example, younger residents had all their exams postponed as well as a big part of their training on hold, as they only carried emergency calls. The senior residents, who
usually focus almost exclusively on enhancing the surgical training in the last months of residency training, had that taken away from them. Additionally, board examinations were postponed across the country.
Some freshly graduated ophthalmologists had a tough time as well, especially those who had set up their private practices a few weeks or months prior to the lockdown. The first period of private practice, which is usually tough on everyone, was particularly challenging in this pandemic. The financial burden specifically has been a concern to these young ophthalmologists, who usually commit to large loans in order to provide necessary costly equipment for a basic ophthalmology practice. Subsequently, the Moroccan society of Ophthalmology deployed a team to investigate the different effects on practices in the private sector in order to come up with adequate solutions.
On the bright side, when it comes to continuous medical education, this crisis was an opportunity in disguise. Excellent educational content flourished in this period with emergence of virtual grand rounds, scientific webinars and open access to most of what used to be exclusively presented in conferences and meetings.
And although this has been tough on young ophthalmologists, it probably gave a good, arguably needed, push to the incorporation of telemedicine, as many were obliged to explore different means to provide eye care to their patients despite the lockdown.
Young ophthalmologists were among those drafted in to fight the COVID-19 pandemic in Morocco. Imane Tarib MD reportsImane Tarib, Senior Resident Ophthalmology, Military Teaching Hospital Mohammed V, Rabat, Morocco and Founding President Young Ophthalmologists of Morocco (YOM) Imane Tarib MD
“One machine can do the work of fifty ordinary men. No machine can do the work of one extraordinary man.”
Elbert Hubbard.
We clinicians, as a matter of course, often poke our heads above the parapet. Arguably, this is most evident in the field of ophthalmology. Through our efforts we attempt to be extraordinary, so that our patients can partake in the ordinary. The ingenuity of pioneers like Sir Harold Ridley, having the swiftness of mind and boldness of character to attempt the first intraocular lens implant in 1949, underpin this remarkable attribute.
Advances in technology are undeniable, as is our ever-growing dependence upon it. Again, this is probably most apparent within the ophthalmic specialty. Our development of robotics as a human race, and more specifically robotics in medicine, is astonishing.
Ophthalmic surgery is relatively unique in its demand for dexterity with minuscule tissue structures within a limited surgical area. This has necessitated the requirement for superior levels of function. Robotic technology offers significant improvements in movement control and precision, tremor cancellation, enhanced visualisation, increased range of motion, and distance sensing. This technology can now offer three-dimensional views with superior instrument manoeuvrability and decreased error outcomes. Howard Larkin befittingly authored an article in the April issue of EuroTimes titled ‘Robotic surgery getting closer’. He outlines the recent development of the automated cataract platform, IRISS (Intraocular robotic interventional surgical system), by Dr Jean-Pierre Hubschman and his team at the Stein Eye Institute and the Advanced Robotic Eye Surgery Lab at UCLA. The IRISS system extracts the lens nucleus and cortical remnants after 3D construction of the eye via pre-operative OCT scanning. Specifically, planning includes ascertaining the trajectory of instrument tips in an effort to reduce complications such as capsule rupture. In a study involving porcine eyes, no
posterior capsule ruptures were noted and completion time of lens removal averaged less than five minutes. Dr Hubschman and his team expect a prototype to be ready for human trials in less than five years. However, it is my firm belief that clinicians will never be replaced by a robot to perform cataract surgery. I view the two as existing together in symbiosis, providing a service that is technically more astute while having the clinician in ultimate control and offering important human interaction. This sentiment is shared, it would seem, not only by surgeons, but by the individuals who are constructing these robots. Another interesting and informative article in the aforementioned publication highlights this. It was penned by consultant vitreoretinal surgeon, Dr Leigh Spielberg, and is titled ‘Highprecision treatments with robotic assistant’. Although this article mainly alluded to the use of robotics in vitreoretinal surgery, pertinent points for all ophthalmic surgery are explored. The article specifically mentions a Dutch company, Preceyes, that has developed an intuitive robotic assistant that has improved precision by almost completely eliminating hand tremor. Accuracy has been increased tenfold allowing for intraocular precision of ten microns or less. What struck me most however, was the comment made by Preceyes’ Chief Medical Officer, Dr Marc de Smet, in relation to the purpose of the robot: “The robot supports the surgeon by improving existing surgery and enabling the development of new, high-precision treatments.” He stresses that the intention of the robot is not to replace the surgeon or even to perform surgeries independently. It is to be viewed as an ancillary tool, reducing surgeon stress and allowing for improved surgical outcomes.
Recent events have highlighted the
sacrifice and commitment that clinicians make. The outbreak of COVID-19 has called all healthcare professionals to task and the global reaction has been overwhelming. Here at home, we have had Irish doctors returning from all corners of the globe to assist us in our national effort. Certain technologies are being used worldwide to great effect, even if their use is morally questionable. These include the assignment of QR (quick response) codes to individuals depending on the status of proximity to known COVID-19 cases, in countries such as China. This allows for near-constant tracking of people, in an effort to localise the virus’ spread and damage.
In spite of all this amazing technology, along with our advancements in robotics, it is ultimately the clinicians and healthcare workers who are on the front-line and delivering care to affected patients, sometimes at their own peril. Li Wenliang, a fellow ophthalmologist and now world renowned ‘whistleblower’ who has been ‘martyred’ by the Chinese communist party, epitomises this intrinsic advocacy. It is this human sacrifice, interconnection, and empathy that is irreplaceable. It is what defines the medical profession and our duty as doctors. These human traits cannot be forged on computer screens or in factories. These inherent attributes, what defines the clinician, are invaluable and cannot be replaced.
Dr Bourke is a Senior House Officer surgical trainee currently working in Cork University Hospital, Ireland

...technology can now offer threedimensional views with superior instrument manoeuvrability...
Robots can never replace the subtleties of human interaction, Dr Minji Jennifer Kim explains in her shortlisted essay for the 2020 John Henahan Prize
No.” This was the short answer received from my grandmother when I asked if she would ever consider having her cataract surgery performed by a robot. Coming from a patient who had undergone cataract surgery over 10 years previously, her reasoning was simple and straightforward.
She clearly recalls lying stiff on the operating table, waiting for her cataract procedure to start. As her surgeon enters the operating theatre, he immediately picks up on her anxiety from the awkward silence in the air and tightly crossed hands pressed into the middle of her chest. Instead of placing the eye drape, he paused and spoke directly to her. This was unusual in those days and even more surprising for my grandmother, she was asked whether she wanted the radio on! She was reassured that would be okay to move or cough as long as she gave the surgeon a little notice. Throughout the 15-minute procedure he constantly spoke to her and put her at ease. Time flew by which otherwise would have felt like a lifetime to her. Had a robot entered the room that morning her experience would not have been the same. She remains forever grateful to the surgeon even today.
On my operating days, I ensure that I arrive early. Of course, paperwork needs to be filled and checklists completed, but to me this is not the most important part of the preparation that morning. No, to me, the most important part is the few minutes I spend meeting patients and their relatives in person. This 60-second act may seem trivial; however, I believe that this allows me to gather a vast amount of information about the patient and how I am going to tailor the surgery for them; what I call the Sherlock Holmes moment. For example, I once met a patient wearing a faded Rolling Stones t-shirt and upon noticing this asked which particular Rolling Stones songs he would like to hear in the background during his operation, which immediately put him
at ease. He finally settled on “It Won’t Take Long”, which I think was a strong subliminal message! Next, I noticed his nicotine-stained fingernails and made a mental note to myself that he may cough unexpectantly and to be particularly careful during rhexis creation. Finally, I spot a small surgical mark on his knee. I explain to him that we will ensure that he is comfortable before we start and will use an extra pillow to help. He is now visibly more relaxed and even manages a smile. Having invested this small amount of time and building rapport prior to surgery, both the patient and I now feel prepared for what is ahead for us both.
Robotic surgery is not new. It has been around for many years, successfully tried and tested in various surgical specialties. Cataract surgery, however, is different. Most cataract operations take place whilst the patient is fully awake, their senses heightened by a mix of fear and anxiety. It is therefore the teamwork between the surgical team and the patient that makes this ‘good’ surgery truly ‘great’. In my grandmother’s opinion, it is the experience of the surgery that is paramount and not whether a robot can make a perfectly-centred rhexis.
Of course, there will be times when robots can be of assistance. The recent COVID pandemic made many of us realise how useful robots can be at times when humans are unprepared. There are currently robots roaming supermarkets, alerting customers to wear masks and maintain appropriate social distance. Some hospitals have adopted robots to take blood samples and swabs. This may become even more topical as there is
significant debate whether cataract surgery is aerosol-generating, and if indeed so, how much protection and testing is required for both the patient and surgeon to be safe. It is not unreasonable to assume that artificial intelligence will become increasingly apparent in healthcare in the next few years and become an integral part of it. The reality is, it has never been technology versus humans. The purpose of technical innovation has always been to be helpful as we all play on the same team.
Robots may be capable in polishing the capsular bag to perfection without worrying about catching COVID. What they are not prepared for is when the patient suddenly coughs and asks whether they could use the toilet during surgery. There is no algorithm that could predict this and interpretation of subtle human interaction is currently far beyond their reach, yet innate to us as clinicians and as people. Robots will always need humans and this is why clinicians will never truly be replaced by a robot to perform cataract surgery.
Dr Minji Jennifer Kim is a Specialist Registrar at the Manchester Royal Eye Hospital, UK

This 60-second act may seem trivial; however, I believe that this allows me to gather a vast amount of information about the patient and how I am going to tailor the surgery for them...
Istoically resist the urge to adjust my surgical mask despite each exhalation of breath partially fogging my spectacles, silently berating myself for forgetting to place tape over the bridge of my nose. The ‘one size fits all’ disposable plastic gloves I am wearing are at least a size too large, and hamper both tactile feedback and manual dexterity. Most importantly, I am conscious of maintaining my distance from anyone in close vicinity. I close my eyes and reflect on how a tricky capsulorhexis would progress in my current attire.
Today, however, I am not in a surgical theatre. I am simply waiting to pay for my groceries at the local supermarket.
The COVID-19 pandemic has had profound effects on all healthcare professionals, including ophthalmologists. Ancient stethoscopes have been dusted off. Old clinical knowledge revisited. Clinic and surgical set-ups adjusted. All hands on deck to help battle a new enemy. However, patients with cataracts continue to lose vision, with accompanying detrimental effects on quality of life amidst a global lockdown. In such unprecedented times, one begs the question: what if we had robots to call upon to perform cataract surgery on our patients instead?
Robot-assisted surgery has been used successfully for years in other surgical specialities including neurosurgery, general surgery and urology. Most notably, it has allowed fine-tuning of a more minimally invasive approach, thereby enabling less surgical trauma and faster post-operative recovery. In ophthalmic surgery, animal models have shown some early promise. For example, studies have shown the robotassisted intraocular robotic interventional surgical system (IRISS) to complete successful capsulorhexis, irrigation/ aspiration, and even lens extraction in animal eyes. The dawn of robots performing cataract surgery is not a completely alien concept as it can be argued that in femtosecond laser-assisted cataract surgery (FLACS), we have already experienced somewhat of a prelude to robot-performed cataract surgery (RCS). In fact, FLACS is already marketed as a form of robotic cataract surgery in parts of the world.
After 15 years of FLACS, however, the jury appears to be out, with evidence suggesting that it is not superior to conventional phacoemulsification cataract surgery and moreover, the increased associated costs do not justify its widescale use. Nonetheless, the option of FLACS certainly adds to an ophthalmologist’s surgical armamentarium, especially in selected cases.
The concept of RCS does bring some potential advantages to the table. In the current climate, the need to maintain social distancing (even in clinical settings) is important in order to keep both clinicians and patients safe. RCS effectively removes the need for surgeons to be in close contact with patients and can allow an adjusted elective surgery service to resume, a notion already championed in gynaecological surgery5 Having such robots ‘on standby’ would be a useful contingency to call upon in any future pandemics we face. The potential mainstream use of RCS can also eliminate any inter-surgeon variability in terms of performance, thereby allowing all patients to receive the same level of care.
The various surgical and patient factors in cataract surgery present several hurdles that need to be overcome during the development of a safe robotic system. Prior to starting a case, cataract surgeons plan accordingly based on the specific complexities of each case, as well as adjusting to any unexpected intraoperative challenges. Developing a robot to ‘adapt’ to the plethora of potential intraoperative difficulties will be a tall order, although recent breakthroughs in technology and engineering suggest that this is far from impossible. It is important to consider the caveat, however, that the utilisation of RCS will deskill generations of ophthalmologists. In turn, ophthalmologists will not only be less equipped to operate on the complex cases, but they will also be more ‘rusty’ in dealing with any robot-induced complications. Hence, cases for RCS may need to be carefully selected.
A considerable amount of research is still required before we see the first robotic cataract surgeon. In the current milieu where a pandemic is accompanied by an
impending global recession, the arrival of robots in ophthalmic theatres may be further delayed. The likely associated high costs of any future RCS will be a further deterrent to its universal use, particularly when compared with an already efficient modern-day phacoemulsification cataract surgery service (performed by humans no less!) where the majority of cases are completed as a day case.
It is fair to say that when I first considered the idea of robots performing cataract surgery in place of clinicians, my initial instincts were a mixture of scepticism and an almost stubborn resistance. Fast forward several months where social distancing and a depleted medical workforce are in play during a global pandemic, it can be argued that there is indeed a place for RCS in ophthalmology. There will always be a need for the human cataract surgeon. But rather than stepping aside for artificial intelligence in the long run, we can utilise RCS judiciously to provide the best possible care for our patients. But until that day comes, we will continue to manage with our human hands.
Dr Khayam Naderi is a UK ophthalmology ST5 trainee currently studying for a two-year MD (Res) fellowship in Anterior Segment & Cataract Surgery at St.Thomas’ Hospital, London, UK

will help, rather than replace the doctor
Most notably, it has allowed fine-tuning of a more minimally invasive approach, thereby enabling less surgical trauma...


Maximum refractive power of the eye is at the front surface of the cornea because of the significant difference in refractive indices between air and cornea. Keratometers and topographers give measurements of anterior corneal surface and thereby of anterior corneal astigmatism (ACA). However, we know now that despite the low difference in refractive indices of aqueous and stroma, posterior corneal astigmatism (PCA) does affect total corneal astigmatism (TCA), contributing an average of about 0.50 Dioptres (D) of against-therule (ATR) change.
TCA may be roughly calculated from ACA by using simplified Javal’s rule: “TCA=ATR_ACA@180o + (+0.50@180o)” or “TCA=WTR_ACA@90o + (-0.50@90o).” This implies that TCA is generally less in case of with-the-rule (WTR) ACA and therefore using keratometric values alone can result in overestimation of the astigmatism by 0.5-to-0.6D and thereby an overcorrection.
Similarly, TCA is generally more in case of ATR ACA resulting in underestimation by 0.2-to-0.3D and under-correction of astigmatism if treatment is based on ACA alone. According to a 2009 study by Ho et al, PCA on an average caused reduction of TCA by 13.4% and in approximately 30% of eyes, PCA caused a change in TCA by >0.5D or by >10o in meridian from ACA.
For a long time, the reason for suboptimal results after toric IOL implantation was unclear and was attributed to lenticular astigmatism and even to the retina. However, recently, the posterior cornea has been studied in much greater detail. Koch et al’s paper from 2012 that analysed 715 corneas of 435 consecutive patients found that the steep corneal meridian was aligned vertically, between 60 and 120o in 51.9% of eyes for anterior surface and 86.6% of eyes for posterior
Refraction of incoming rays at the steep (red) and flat (blue) meridia on the anterior surface of an astigmatic cornea is shown. Irrespective of anterior corneal astigmatism, the posterior cornea generally has steep (pink) axis in the vertical meridian causing an against-the-rule astigmatism. The red and blue bold lines and the image lines “a” and “b” show refraction as would be presumed to occur without considering the effect of posterior corneal astigmatism (PCA). The light blue and pink dashed lines and image lines “c” and “d” show the actual refraction occurring at the posterior corneal surface. A Shows overestimation of WTR astigmatism that occurs if PCA is not taken into account. B Shows underestimation of ATR astigmatism that occurs if PCA is not taken into account.


surface. Since the posterior cornea is a negative lens, however, the vertically steep posterior curvature results in a net positive power in the horizontal direction or an ATR astigmatism.
They also found that with increasing WTR ACA, the PCA can also increase,
even up to 1D. However, this is not the case with increasing ATR ACA, where mean PCA remains relatively same. In addition, with increasing age, the anterior cornea tended to change from WTR to ATR, yet this drift was not seen in the posterior cornea. A 2015 study by
In the first of two articles, Dr Soosan Jacob MS, FRCS, DNB highlights the relevance of posterior corneal asitgmatism
Hiyashi et al also showed an ATR drift of 0.2-to-0.4D in all age groups, during a 10-year follow-up in both post-cataract surgery as well as no surgery groups, with the drift further continuing over 20 years, as shown in their 2017 follow-up study. Another interesting study was by Ueno et al, using swept-source OCT, which showed that the cornea is thicker along the vertical than the horizontal meridian, and this could contribute to ATR astigmatism by creating a steeper vertical cornea posteriorly. This difference was found to increase with age, which could partially account for the ATR drift in old age. Another finding was that the superior cornea was thicker than the inferior cornea and could possibly contribute to some higher-order aberrations.
This may be done by newer and better tomographers, such as Scheimpflug imaging, slit scanning, OCT and reflective LED imaging, that allow measurement of the posterior cornea. However, accurate measurement of the posterior corneal curvature is still not possible and this led to the development and popularity of the Baylor nomogram. Another popular option is to use a theoretical approach such as used in the Barrett toric IOL calculator (www.ascrs.org).
BAYLOR NOMOGRAM
This regression approach based on population averages was proposed by Koch et al in their 2013 study to correct overestimation of WTR
and underestimation of ATR. The surgically induced astigmatism (SIAusually between 0.2 and 0.3D for most surgeons) is first factored in, followed by IOL’s spherical power and its position in the eye as these can affect the toricity at corneal plane. The nomogram then corrects for PCA by increasing or decreasing from that IOL power. It also factors in an additional adjustment to leave patients with slight WTR astigmatism to counter the ATR drift that occurs with ageing. These adjustments lead to a change in threshold for implanting toric IOLs to about 1.7D of WTR and 0.8D of ATR ACA after factoring in of SIA.
Many patients with oblique astigmatism may be considered to be midway in the age-related drift from WTR to ATR and these patients should be targeted on or only slightly below measured astigmatism. The toric IOL should therefore be aligned on axis or towards ATR axis and not towards the WTR axis in order to hold good for a longer time during the ATR drift.
BARRETT TORIC CALCULATOR
This incorporates the patient’s PCA and effective lens position (ELP) values
rather than using population averages. However, it is based on a theoretical eye and PCA and ELP are predicted rather than measured though recent updates allow input of measured values as well. It uses anterior chamber depth (ACD), axial length, toricity ratio and SIA centroid for its calculations. For calculation of spherical equivalent IOL power, it bases itself on Barrett Universal II formula, where ACD is related to axial length and keratometry and principal plane of refraction of IOL is a variable. The Barrett True K Toric calculator is used in post-refractive surgery eyes.
Other formulae in use for toric IOL calculation include ASSORT calculator, Savini calculator, Holladay IOL consultant software etc.
To conclude, PCA is important for estimating power of the toric IOL to be implanted. IOL with less toricity needs to be chosen when correcting WTR astigmatism and conversely, more toricity when correcting ATR astigmatism.
Dr Soosan Jacob is Director and Chief of Dr Agarwal’s Refractive and Cornea Foundation at Dr Agarwal’s Eye Hospital, Chennai, India and can be reached at dr_soosanj@hotmail.com

...we know now that despite the low difference in refractive indices of aqueous and stroma, posterior corneal astigmatism does affect total corneal astigmatism
Abright future with sustained market growth and continued innovation in all domains of ophthalmology – that was the clear message to emerge from the 2019 European Ophthalmology Futures Forum held in Paris, France.
“We are now on our eighth European Forum,” said Keith Barton MD, FRCS, co-chair and co-founder of the Ophthalmology Futures Forum along with Kuldev Singh MD, MPH. “Since we first came up with the idea in the back of a car on the way to ARVO in 2012, Ophthalmology Futures has grown dramatically.
We have had two standalone Retina Forums, one here in this venue last week and three Asian Forums and a few other events in Chinese meetings. The future in the ophthalmic space seems very bright and destined to continue growing,” he said.
Founded in 2012, the Futures Forums are clinician-driven innovation meetings focusing on new technology, entrepreneurial ventures, market access and other aspects of commercialisation in the ophthalmic healthcare sector. They cover all aspects of global innovation in ophthalmic devices, diagnostics and pharmaceuticals by connecting scientists, physicians, regulators, reimbursement specialists, corporate leaders, venture capitalists and other investors who support the advancement of eye care.
Delving into key issues of relevance to the field of ophthalmology, the opening debate at the Forum focused on the growing array of solutions for presbyopia. Chaired jointly by Sheraz Daya MD, FRCOphth, Chairman and Medical Director of Centre for Sight, United Kingdom, and Arthur Cummings MD, Consultant Ophthalmic Surgeon and Medical Director, Wellington Eye Clinic, Dublin, Ireland, panellists were asked to discuss the range of solutions they offer to their presbyopic patients.
Gerd Auffarth MD, FEBO, Professor and Chairman of The Department of Ophthalmology, Ruprecht-Karls University of Heidelberg; Director of the IVCRC and The David J Apple International Laboratory of Ocular Pathology at The University-Eye Clinic of Heidelberg,

Germany, said that there was no “one size fits all” approach for presbyopia.
“We offer corneal approaches with inlays or laser as well as a wide varies of intraocular approaches including trifocal, multifocal and accommodative IOLS. We are covering an age spectrum from late 40s to early 60s or mid 60s so we have to apply a range of technologies to account for differences in age, refraction and other variables,” he said.
Aylin Kiliç, Associate Professor, Istanbul Medipol University, Turkey, said that in addition to multifocal IOLs, she has recently been involved in a clinical trial of a novel allograft corneal inlay (Transform, Allotex).
She explained that the inlay is a piece of acellular cornea prepared from eye bank tissue that is sterilised with electron beam radiation and shaped using an excimer laser. It has a refractive add power of +2.5D and is designed to improve near vision by increasing depth of focus and corneal power in the non-dominant eye.
“We have about two years' follow-up with this technique and the results have been amazing, with no cases of clinically relevant haze, corneal opacities or foreign body sensation in that time. The procedure is reversible and it is a very positive about this approach,” she said.
Erik Mertens MD, FEBO, PCEO, Medical Director and Eye Surgeon, Medipolis, Antwerp, Belgium, said that he has switched from corneal approaches such as SupraCor excimer laser and Kamra inlays.
“I had to remove about half of the inlays I was implanting so I decided to stop. The only inlay I use now is the Allotex allograft corneal inlay. For intraocular procedures and refractive lens exchange, I use the multifocal EDOF lens and in this regard we are currently awaiting the results of the multi-centre study of the EVO+ Visian ICL (Staar Surgical),” he said.
Dr Daya noted that while there is a wide range of options available to surgeons for their presbyopic patients, the reality is that surgeons usually offer a simplified choice to keep chair time to a minimum and make life easier for the entire surgical team.
Dr Kiliç agreed and said that in addition to the new allograft inlay, there is still a lot of demand for LASIK monovision, which “works well for a lot of patients but which is far from perfect”.
Dr Auffarth said that while narrowing the options made sense from a practice efficiency perspective, it was not something that could satisfy all patients.
“If we really are focused on one device or one procedure then it is possible from a commercial point of view to train the entire staff to examine and preselect the patients with that procedure in mind, and do about 80% of patients successfully in this way. However, we will have to explore other options for the remaining 20% or you can refer them elsewhere and let somebody else handle it. Even though every doctor would like to be able to offer a single solution, it remains patientbased and they may need different options,” he said.
Plano presbyopic patients pose one of the more formidable challenges for surgeons, said Dr Mertens.
“They usually only use glasses for reading and every procedure that you do they will lose distance vision and often end up dissatisfied. For the rest of my presbyopic patients, I use phakic IOLs a lot and less laser refractive surgery because this approach is more reversible. And in terms of inlays I only use the Allotex allograft corneal inlay which is biocompatible and avoids a lot of the issues with other inlays,” he concluded.
Since we first came up with the idea in the back of a car on the way to ARVO in 2012, Ophthalmology Futures has grown dramatically
Keith Barton MD
Areview of more than 2,000 patients who underwent small-incision lenticule extraction (SMILE®, CZM) over the past seven years indicates that the procedure only rarely has intraoperative complications, reports Detlev R.H. Breyer MD, Dusseldorf, Germany.
“We are still smiling and moved completely from LASIK to SMILE, whenever possible” Dr Breyer told the 24th ESCRS Winter Meeting in Marrakech, Morocco. “No flap complications, no dry eyes.”
Dr Breyer and his optometrists analysed videos from 2,165 consecutive eyes undergoing SMILE procedures performed at the Breyer-Kaymak-Klabe Eye Surgery & Premium Eyes in Düsseldorf, Germany.
He noted that the SMILE procedure was completed in 2,143 eyes (98.98%) and aborted in 22 eyes. No patient lost more than one line of best-corrected visual acuity. Suction loss occurred in 15 eyes (1.25%), among which the procedure was completed in five eyes, but was aborted in 10 eyes. Among those 10 eyes, two underwent implantation of an implantable collamer lens (ICL) and three resumed wearing spectacles or contact lenses.

“The good thing is that the patient’s vision will not be harmed by the procedure when it cannot be completed due to suction loss. The time of potential flap complications is gone.”
Dr Breyer tells his patients in the informed consent to reduce fear and make them feel safe and well kept.
One patient developed late keratectasia. The patient had forme fruste keratoconus preoperatively and was informed of the risk of the complication. The keratectasia began at six months but was successfully treated with accelerated protocol iontophoresis corneal cross-linking (CXL) and at five years the cornea remains stable and best-corrected visual acuity is 0.5 whereas BCDVA before surgery was 0.4. There were also three eyes in which the lenticule could not be removed, among which one eye underwent transepithelial PRK and two underwent ICL implantation. Meanwhile, only eight eyes required refractive retreatments, including PRK in seven eyes and ICL implantation in one eye, Dr Breyer said. He noted that the retreatment rate was fairly low, considering that the interrupted series of patients started with their first patient at the Düsseldorf Centre at PremiumEyes, at a time when only around 10 centres around the world were performing the procedure.
He explained that over the years, surgeons have learned techniques for dealing with the complications that may occur. For example, in cases where there is incomplete dehiscence of the lenticule, it can often be removed with relative ease using a rhexis forceps, a technique Sri Ganesh from Bangalore introduced. He added that black spots have become less common as experience with the procedure and knowledge of appropriate energy settings has increased.
“There was definitely a learning curve. SMILE is not LASIK, it is not an excimer laser procedure. SMILE is more corneal surgery than laser surgery,” he stressed.
Major review shows safety and consistency of SMILE procedures. Roibeard Ó hÉineacháin reports
Cataract surgery in eyes with pseudoexfoliation can be very stressful, but there are many tools and techniques available to deal with its principal difficulties such as poor pupil dilation, and more important progressive zonular dehiscence preoperatively intraoperatively and postoperatively, reports Betty Lorente MD, FEBO, University Hospital, Ourense, Spain.
“The goal is to maintain the capsular bag in place to avoid inflammation through excessive manipulation, minimising complications and implant the lens in a safe position,” Dr Lorente told the 24th ESCRS Winter Meeting in Marrakech, Morocco.

She noted that in her region the rate of PEX among patients scheduled for cataract surgery is particularly high at 22% among those over 70 years and 33% among those over eight years. She added that every case of pseudoexfoliation is different and she presented the set of guidelines used at her centre to deal with most types of cases.
In eyes with PEX, the cataract surgeon should also be prepared with adequate tools for miosis, every degree of nuclear hardness and zonular weakness, she said. For example, she noted that she always likes to keep diluted triamcinolone at hand in case an anterior vitrectomy becomes necessary. It not only helps visualise any vitreous brand but also has an antiinflammatory effect postoperatively.
In eyes with PEX, preoperative exploration is very important, the cataract procedure

begins before the patient enters the operating room, even before instillation of mydriatic drops, since phacodonesis is best observed in miosis. It is also important to look for indirect signs of zonular dehiscence such as an asymmetric anterior chamber depth, Dr Lorente said. She usually uses local anaesthesia, but peribulbar and sub-Tenons may be considered for cases requiring longer and more difficult cases. For pupil dilation, iris hooks – or capsular hooks – are the preferable tool in PEX cases, not only for
economic reasons but also because they can help stabilise the capsular bag during the surgery. Once the capsulotomy is completed, the hooks may then be moved to the capsular rim if necessary, to stabilise the bag during the phaco.
Dyeing the capsule with trypan blue can assist in capsulotomies. However, in eyes with zonular damage the dye can leak into the vitreous cavity causing loss of the red reflex. To avoid this problem we can stain the capsule injecting two-to-three drops of dye under the visco and “paint” it with the spatula. Hydrodissection should be performed multizonally, gently compressing the lens to prevent capsular blockage and rotating the nucleus with a bimanual approach to apply the force more evenly on the weak zonula and provide better control.
The role of the capsular tension ring (CTR) in PEX patients is controversial. Some
The goal is to maintain the capsular bag in place to avoid inflammation through excessive manipulation
Betty Lorente MD, FEBOCourtesy Betty Lorente MD, FEBO
authors advocate their use in all such cases. However, she said that in her experience CTRs are not necessary in all cases and do not appear to improve clinical outcomes. Besides which they can damage the zonule even when placed as carefully as possible.
She added that at her centre, CTRs will generally first be considered only if signs of zonular damage are present – as oval shape of the CCC – and if this damage is less than four hours of the circumference.
She noted that CTRs should be implanted as late as possible during the procedure. Placing too early will make later manoeuvres to remove the lens more difficult. Placement of the ring is best achieved with a two-handed approach

placed towards the area of zonular damage. Attaching a 10-0 nylon suture to the can be a useful precaution, should the ring need to be withdrawn, as would be the case in subluxation of the lens.
In eyes with weak zonules phacodissection begins with chop, or stop-andchop technique. However, she advises her residents to use the technique they are most comfortable with. A good divide-and-conquer is better than a bad chop, she stressed.
Young ophthalmologists must also learn techniques now rarely used, including intracapsular cataract extraction, when dealing with PEX cases. “Phacoemulsification has its limits and a subluxated lens with a hard nucleus and PEX is one of them,” she said.
She noted that she reinjects viscoelastic many times in her PEX cataract procedures, both to protect the endothelium and maintain the anterior chamber. For example, before withdrawing phaco tip at any time during surgery she first injects some viscoelastic. In hard cataracts she usually creates a small crater in the centre of the nucleus and then chop (six-to-eight fragments). She performs bimanual aspiration of the cortex and polishes the anterior part of the capsular bag that is going to be in contact with the IOL to avoid capsular contraction. Postoperatively, relaxing capsulotomies should be performed when there is any
sign of capsular contraction to prevent capsular tension syndrome.
In all patients it is necessary to avoid postoperative IOP spikes, and it is particularly true in eyes with glaucomatous pseudoexfoliation. A useful measure in such eyes is to aspirate the viscoelastic near the trabeculum, Dr Lorente said.
Dr Lorente cautioned that even in a perfectly performed and uncomplicated procedure, one should be prepared for unexpected complications, such as late subluxation of an IOL.
“Pseudoexfoliation is not your friend; sometimes you think you’re just at the end of your procedure and then you’re only at the beginning, again,” she commented.
Betty Lorente: bettylorente@gmail.comEyestar 900 features precise cornea-to-retina measurements, topographic assessment of the front and back corneal surface, the anterior chamber (including the lens) and imaging of all these structures.

The fully automated measurement process enables the user to reliably acquire precise measurement and swept-source OCT imaging data of both eyes in less than 40 seconds.
An

Phacoemulsification has its limits and a subluxated lens with a hard nucleus and PEX is one of them
Betty Lorente MD, FEBO
investment in the Eyestar 900 is an investment in the future. With periodical software updates, Haag-Streit is constantly adding new features and capabilities to ensure that the Eyestar 900 meets and exceeds your needs throughout its lifespan.
All swept-source OCT precision measurements and imaging for greater safety and improved outcomes. «
EUROCOVCAT is a group of cataract and refractive surgeons which has met on Zoom several times to discuss how to get back to practising ophthalmology in the most safe, efficient manner in the months and years ahead. This article, the second of two articles written exclusively for EuroTimes , provides an insight on how to rethink cataract care
Garcia-Gonzalez Montserrat, University of Alcalá, Rementería clinic, Madrid, Spain, Gros-Otero Juan, CEU San Pablo University, Rementería clinic, Madrid, Spain; Aslan Bekir S, Ankara Memorial Hospital, Ankara, Turkey; Carones Francesco, Carones Vision, Milan, Italy; Cummings Arthur B, Wellington Eye Clinic, Dublin, Ireland; Darcy Kieren, Bristol Eye Hospital, UK; Gundersen Kjell-Gunnar, Ifocus Øyeklinikk, Haugesund, Norway; Malyugin, Boris S. Fyodorov Eye Microsurgery Federal State Institution, Moscow, Russian Federation; Mrochen Michael, IROC Science to Innovation, Zurich, Switzerland; Murta Joaquim, Coimbra University, Portugal; Teus Miguel-Angel, University of Alcalá, Madrid, Spain.
Our recommendations should be used in accordance with local guidance from health authorities and national ophthalmic societies.
1. Close monitoring for staff:
a. Daily temperature measurement in addition to self-monitoring symptom questionnaires
b. Strict hand hygiene
c. Wearing masks, as it is not possible to maintain the two metres of social distance suggested by WHO
d. Once in the operating room, standard rules for sterile surgery may apply: wearing surgical gown, masks, gloves and hair cap. Refractive surgery is performed through a surgical microscope, making use of a face shield or goggles more difficult. Manoeuvres oriented to decrease aerosols during surgery are encouraged e.g. the use of HPMC and smaller incision sizes during phacoemulsification.
e. Staff shift patterns need to be determine locally, depending on the size of the workforce of each clinic/hospital.
2. Social distancing, patient safety and consent: The number of patients per hour will vary dependent upon the capacity of the waiting room, the number of staff working simultaneously and the physical flow of the clinic. Increasing opening hours can help compensate, but it is essential this is balanced against the additional cost and welfare of the staff. Our patients’ safety must be prioritised. Regulatory requirements vary around the world, but an effective informed consent process should remain a central tenet of best practice. It may be in the patients’ best interest to perform the initial consultation virtually to minimise any unnecessary visits. Throughout the process, a clear line of dialogue should exist between the patient and operating surgeon.
3. Correct patient engagement and communication flow: Sending patient videos detailing what to expect before the visit and the sequence of the day is likely to improve the efficiency and flow whilst in clinic. Educating them of the
PPE and social distancing protocols being followed in the clinic will also provide additional reassurance. Videos describing the procedures that are potentially suitable enables a more concise and succinct discussion, whilst simultaneously improving the consent process. It may also be helpful to address additional issues such as the possibility of any existing dry eye so that lubricants could be started even before the first visit. This reduces both the risk of deferring surgery and any additional face-to-face consultations required for reassessment after a period of dry eye treatment. Use social media to show the safety guidelines to which the clinic adheres
4. Clinic and staff resources: Each clinic will have differing capacity constraints Addressing this will need a localised approach, but some suggestions are:
a. Extend opening hours
b. Increase clinical space or the number of offices
c. Hire new consultants
d. Stagger patient visits
5. Virtual consultation/telemedicine: We recommend different approaches for the preoperative and postoperative visits:
a. Preoperative: Virtual consultations can be utilised to perform an initial consultation where targets are being discussed and goals set. Face-to-face consultations should be reserved for scans, performing a physical exam and debriefing only. Try to determine which scans are required during the virtual consultation to improve flow and efficiency during the face-to-face consultation, but examinations may need to be extended if unexpected findings appear during the visit. A number of clues can be used to assist this, such as age, refractive error, the presence of presbyopia, etc. If the post-examination discussion is protracted, complete this virtually, even whilst in the clinic setting. The doctor and patient should be in different rooms with the use of video technology.
b. Postoperative: This will need tailoring to the procedure undertaken. We recommend avoiding telemedicine for early follow-up
visits (24 hours and first week visit) after LASIK or RELEX procedures, as severe sight-threatening complications could be missed, but for other follow ups (first month or three-month post-op visits), this might be a very valuable option. In contrast, following surface ablation, the 24-hour visit may be substituted for a phone call, but it then becomes mandatory to review these patients around five-toseven days post-op to check the epithelial integrity and remove the bandage contact lens. Postoperatively, virtual consultations can be very helpful. Although direct examination is not possible, the patient can be assessed for comfort, their postoperative course and overall satisfaction. An increasing number of apps can be used to assess gross visual acuity testing, contrast sensitivity and even including quantitative measures of visual function and ease of vision.
Patients need to be reassured of the safety measures put into place in each clinic or hospital. This is especially important for elective surgery. Patients have expressed concerns how postoperative care will be undertaken in case of another lockdown. Reassurance should be offered detailing how care will continue with robust plans. Additionally, improving our professional network is useful as we might need assistance from colleagues in other cities/countries to continue our follow up if new lock downs are needed.
Pre-Surgical: Patient Assessment
Ophthalmologists must be considered a high-risk category because of their close contact with patients. Effective hygiene routines and personal protective equipment reduce this risk. However, in addition to close person-to-person respiratory droplet spread, there are two further potential risks points of transmission: direct contact with the conjunctiva and tear secretions, and aerosol created during certain procedures.
We recommend the following adaptations prior to surgery:
1. The first assessment should be done by telephone one-to-three days prior to the visit: checklist questionnaire to assess if the patient has any suspicious symptoms or recent contact with a COVID-19 positive person (in these cases, the visit will be postponed).
2. In countries where period of selfisolation is stipulated prior to surgery, this should be respected.
3. In countries where COVID-19 contact tracing is active, we should encourage our patients to engage with those platforms. Early detection of infection in the postoperative period is of great value to be aware of local complications and avoid further disease spread in our offices.
4. Collect patient information remotely and electronically. Before the appointment, send an interactive electronic history form that includes all the questions that we usually ask in the clinic (age, profession, hobbies / sports, allergies, intolerance to contact lenses, symptoms of dry eye, ocular or systemic diseases, visual expectations…)
5. The patient should preferably come alone to the clinic. The use of mask is mandatory in both the waiting and examination rooms.
6. The same checklist questionnaire must be answered by the patient at the front door of the clinic, prior to entry. A temperature check can be a good screening method, but the absence of fever does not discard an asymptomatic COVID+ patient.
7. Remove magazines, coffee, water and toys from waiting rooms. Chairs should be removed or blocked with signs to maintain a social distance of one to two metres among patients.
8. Do only the mandatory in-clinic exams (i.e. manifest and cycloplegic refractions, corneal topography or tomography, anterior segment OCT, biometry, etc.) depending on the preoperative refraction and the surgical refractive procedure considered. We believe that candidates for corneal refractive surgery must receive a cycloplegic refraction, especially hyperopic patients (to evaluate the grade of latent hyperopia) and pre-presbyopic myopic patients (to avoid the risk of overcorrection of the refractive myopic defect). In addition, a dilated fundus exam is recommended preoperatively in all patients, or as a minimum in patients with a high risk of retinal detachment.
9. Limit communication with the patient during the ocular examination because talking can potentially aerosolise the virus.
10. After each patient, clean with the appropriate disinfecting products, surfaces touched by the patient, the optometrist and/or the ophthalmologist.
11. Informed consent process: the written informed consent should be given to the patients to read and sign it at home prior to surgery. This should be confirmed by
the surgeon on the day of surgery. In the instance that the final treatment decision is taken on the day, patients should have received all the necessary information prior to the appointment. Any protracted discussions should be held virtually within the clinic.
12. The informed consent needs to clearly articulate that COVID-19 infection risk cannot be quantified, and that it will never be zero.
13. A clear line of communication should be maintained between the patient and operating surgeon. Any additional questions about the surgical procedure or the informed consent should be performed by video, phone or email. The question of COVID-19 testing remains under local healthcare guidance. Some countries require PCR testing and a period of self-isolation of all surgical patients before entering the operating room, some even requiring lung x-rays to combat the specific concerns of the COVID-19 tests, while others are relying on questionnaire and temperature check, then treating all patients as if they were positive. Indeed, there are current government obligations in some markets for intense sterilisation, so there is need for more time between patients, reducing the numbers of surgeries per day so the patient management flow and pre-assessments play an important role in the process.
Surgical process and standards: An effective risk assessment of refractive surgical procedures can help to mitigate the risk of transmission to health care professionals and patients. Our recommendations:
1. Reduce the operating schedule to be able to clean and disinfect the operating room, as well as to provide social distance in the waiting rooms.
2. Only patients are allowed into the clinic; non-essential caretakers are asked to wait outside or even in their vehicles, and they are called when the patient is being discharged.
3. Reduce the number of people in the operating room (i.e. one surgeon, one nurse, one assistant and one optometrist).
4. All staff are required to wear surgical masks and gloves, and even face shields or goggles if an aerosol-generating procedure is performed. They should be trained about wearing and removing the personal protection equipment.
5. To sterilise the eye prior to surgery, some surgeons will continue, others will start to use diluted betadine as in cataract surgery, as it is well accepted as a potent disinfectant when applied before surgery. Topical povidone iodine drops prior to corneal refractive surgery for a contact period of two minutes can reduce the effectivity of the SARS-CoV-2 virus below detectable levels.
6. Bigger drapes can be used for added precaution.
COVID-19 has brought several new considerations, to determine the best surgical technique:
a. Excimer laser light is in the ultraviolet range, which is effective in killing any viruses within the treatment zone that may be present on the cornea.
b. A mechanical microkeratome involves a blade oscillating at very high frequency over the corneal surface. Aerosol is only generated if the energy source is enough to overcome particle adhesion and in the presence of an airflow to entrain particles. It has been hypothesised a mechanical microkeratome may achieve this. The use of these devices has significantly reduced since the introduction of femtosecond lasers. However, in the absence of further evidence it may be advisable to consider mechanical LASIK as a potential aerosol-generating procedure and follow the appropriate recommendations.
c. In contrast, a femtosecond laser does not have any vibrating pieces in contact with the cornea and so can be considered a non-aerosolgenerating device.
There are still more questions than answers. To date SARS-CoV-2 has not been found inside the eye. Although SARS-CoV-2 has been detected on the ocular surface, it is still unclear whether the recorded presence is due to active viral replication or indirect inoculation. When detected, its presence appears better correlated with severe, symptomatic disease. This risk is mitigated by the described screening protocols and the use of betadine pre-operatively. The risk of AGP transmission in refractive surgery is therefore very low, which maintains the focus on the usual physical distancing and reduction of respiratory transmission routes. If using mechanical microkeratome for LASIK (AGP), the use of protective shields between the surgical area and the refractive surgeon are recommended, to minimise any potential risk of viral transmission.
There are no “golden rules” about how refractive surgery should be restarted in Europe. Our patients need to be reassured of the safety measurements implemented in each clinic or hospital, and this is of much greater importance from the perspective of refractive surgery, as it is elective. These guidelines are recommended to reduce the risk of COVID-19 transmission, while offering the level of care that our refractive patients demand.
References On Request
Predicting effective lens position (ELP) remains the biggest obstacle to improving cataract surgery refractive outcomes, in part because it is just that: a “prediction” and not a direct measurement. However, adopting best practices in measuring biometry and corneal power, verifying preoperative data and using the best available intraocular lens (IOL) power formulas help reduce other sources of error, improving cataract surgery refractive outcomes, Douglas D Koch MD told Refractive Surgery Day at AAO 2019 in San Francisco, USA.
Preoperative and intraoperative OCT are improving the understanding of ELP and are improving ELP prediction, but no studies using these methods as yet show superior IOL power calculation accuracy, said Dr Koch, of Baylor College of Medicine, Houston, Texas, USA. One big issue is that ELP shifts unpredictably postoperatively, with nearly 18% of patients experiencing a change in anterior chamber depth of 1.0mm or more between one hour and two months after surgery (Hirnschall et al. JCRS 2018;44:1310-1316).
“We may nail [ELP] on the operating room table, but it may change as the patient heals as we have all seen,” Dr Koch said.
ELP is especially problematic in short eyes, reducing the accuracy of IOL power calculations, Dr Koch said. In eyes with axial length shorter than 22.0mm, Dr Koch’s group
found the percentage of patients within 0.5D of target post-op varied from 63% to 78% for seven formulas tested, which was not statistically significant (Goekce S et al. JCRS 2017;43(7):802-7). That compares with 91% for eyes 21.0mm to 29.0mm using Warren Hill MD’s RBF formula, which is the overall best performance Dr Koch has seen reported, and 70-to-80% overall in clinical practice and the literature.
With very short eyes, “you have a high power IOL in a small chamber with variable lens thickness and anterior chamber depth preoperatively, and a small shift gives you a lot of refractive change”, Dr Koch explained.
Conversely, lower power IOLs in longer eyes may contribute to better outcomes because it reduces the impact of ELP shift on refractive errors. Outcomes are better with long eyes using modifications Dr Koch and colleagues developed for the Holladay 1 and 2 formulas, and the Barret Universal 2 and the Hill RBF 2 doing an excellent job also (Wang L, Koch DD. JCRS 2018;44:1396-1397).
In a database of 1,664 eyes 25.0mm or longer provided by Dr Hill, substituting the modified axial length formula for the manufacturers’ using the Holladay 1 formula reduced mean refractive error from +0.23D to -0.08D, and increased the percentage within 0.5D of target from 77.2% to 92.9%. Hyperopic outcomes and mean absolute error also were reduced significantly, Dr Koch said.
By comparison, in clinical practice and the literature, 70-to-80% of surgeries are within 0.5 dioptre of predicted refraction, and outcomes are worse for complex eyes (Melles RB et al,
Ophthalmology 2018;125:160-178). For post-LASIK eyes with no pre-refractive surgery data, 70% of eyes within 0.5D is about the best current IOL formulae can deliver, Dr Koch said.
While predicting ELP may be the largest source of post-op refractive error, difficulties in measuring corneal power also contribute, Dr Koch said. Taking multiple corneal measurements and verifying the quality of raw data go a long way toward improving the accuracy of corneal power estimates.
“It is also the one step we can do the most about in practice.”
Other best practices Dr Koch recommended for increasing the accuracy of IOL power calculations are to use accurate measurement devices, such as optical or swept source biometry, and multizone LEDs for K readings. Educating patients about the fallibility of calculations and their impact on outcomes helps keep expectations in line.
“We are approaching an upper limit for accuracy with preoperative measurements,” Dr Koch said. Postop IOL power adjustment will soon make it possible to correct IOL power prediction errors, whether by changing lens curvature or localised refractive index changes, and Dr Koch believes it will become mainstream.
“These are exciting new technologies that will improve our outcomes.”
Douglas D Koch: dkoch@bcm.edu
Preoperative and intraoperative OCT are improving the understanding of ELP and are improving ELP prediction...
Douglas D Koch MD
We may nail [ELP] on the operating room table, but it may change as the patient heals as we have all seen
Douglas D Koch MDTHOMAS KOHNEN European Editor of JCRS





VOL: 46 ISSUE: 5 MONTH: MAY 2020


Trifocal intraocular lenses (IOLs) are now being implanted in cataract patients as well as those with presbyopia. A new randomised, prospective study compared two diffractive trifocal toric IOLS. Sixty patients were randomised to receive bilateral implantation of either the FineVision Pod FT toric IOL (PhysIOL) or the AcrySof IQ PanOptix toric IOL (Alcon). At three months the study found no significant differences in uncorrected and corrected distance and near visual outcomes between the groups. Contrast sensitivity, quality of vision scores and the level of spectacle independence were similar in both groups. Levels of IOL axis misalignment and magnitude of error of astigmatic correction were also similar. The incidence of photic phenomena was low for both lens types. The study did find significantly better values of uncorrected intermediate visual acuity and distance corrected intermediate visual acuity in favour of the PanoOptix lens. FJ Ribeiro et al., “Comparison of visual and refractive outcomes of 2 trifocal intraocular lenses”, 46(5):694-699.




Does a large angle κ contribute to decentration and poor outcomes in multifocal IOL patients? Researchers evaluated 63 eyes of 63 patients that had bilateral implantation of a diffractive trifocal IOL (POD F, PhysIOL). Pupil offset was used to estimate of angle κ using the Pentacam (Oculus) preoperatively and at three months postoperatively. There was a significant decrease in pupil offset values postoperatively. The study showed no statistically significant difference in any of the refractive and visual acuity outcomes between eyes with small pupil offsets and eyes with large pupil offsets. All but one IOL were perfectly centred. The majority of patients (14 of 16) complaining of significant halos had eyes with small pupil offsets. The researchers hypothesise that the tolerance to larger pupil offset might be due to the IOL optical design, with the first diffractive ring being larger than other commonly used multifocal IOLs. N Garzón et al., “Influence of angle κ on visual and refractive outcomes after implantation of a diffractive trifocal intraocular lens”, 46(5):721-727.



Anterior segment swept-source optical coherence tomography appears to provide reliable sizing information for patients being considered for collamer lens implantation. Investigators obtained preoperative OCT scans for 81 eyes of 41 patients and used NK-formula version 2 (NK-formula V2) data to calculate lens size. Three-month follow-up results indicated that optimisation approach has an ‘excellent ability’ to select an appropriate ICL to be implanted regardless of the value of other ocular parameters and age, other than anterior chamber width. A majority, 91.2%, achieved a moderate degree of vaulting. T Nakamura et al., “Optimization of implantable collamer lens sizing based on swept-source anterior segment optical coherence tomography”, 46(5):742-748.
Lower capsule complication rates often seen among the high-volume cataract surgeons, as well as for most surgeons in recent years, may be due to more favourable case mixes, according to a Swedish National Cataract Register study.
Speaking at the 37th Congress of the ESCRS in Paris, Madeleine Zetterberg MD, PhD, reviewed a study based on data from more than 118,000 cataract surgeries performed in Sweden from 2007 through 2016. It found that surgeons doing fewer than 1,000 procedures annually had higher mean posterior capsule rupture rates than those doing 1,000 or more – 2.15% for those doing 10 to 99 cases, 1.32% for 100 to 499 cases and 0.59% for 500 to 999 cases, compared with 0.48 and 0.47% for 1,000 to 1,499 and 1,500+ cases respectively.

However, the study also found that high-volume surgeons had significantly lower mean case mix risk scores – 1.34 for those doing 10 to 99 cases, 1.49 for 100 to 499 cases, and 1.28 for 500 to 999 cases, compared with 1.15 and 1.14 for 1,000 to 1,499 and 1,500+ cases respectively.
High-volume cataract surgeons have a slightly lower case mix, which may explain their lower rate of capsule complications, said Professor Zetterberg, of the University of Gothenburg, and Sahlgrenska University Hospital, Mölndal, Sweden.
“The difference was not all that great, though. The high-volume surgeons are still
doing a lot of complicated cases.”
Similarly, the study found that case mix risk scores declined slightly from 2007 through 2016. This suggests that improving case mix may also be a factor in improvements in capsule complication rates seen over the period, Dr Zetterberg added.
To perform the analysis, Professor Zetterberg and colleagues first developed a risk score for assessing case mix difficulty. Logistic regression analysis of data on a range of demographic, clinical and operative difficulty parameters found several that were significantly linked with increased posterior capsule rupture.
These were preoperative best correct visual acuity of less than 0.1, or 20/200; pseudoexfoliations; sightthreatening ocular comorbidity; use of trypan blue, which is a marker for dense cataracts; mechanical pupil dilation, which is a marker for small pupils; and iris hooks at the rhexis margin, which represent zonular dehiscence.
“These were all very highly associated with increased capsule complications,” Dr Zetterberg noted.
A composite risk score was created based on these parameters by multiplying out the odds ratio for each parameter. A score was assigned for each cataract case. Individual risk scores were averaged for each surgeon and for each volume group.
For surgeons with 100-499 cases, per surgeon mean risk scores ranged from 1.01 to 5.19, with individual risk scores for patients in this group ranging from
1.00 to 62.90. For surgeons with 500999 cases, per surgeon mean risk scores ranged from 1.00 to 2.02 with individual patient risk scores from 1.00 to 62.90. Surgeons with 1,000 to 1,499 cases saw per surgeon risk scores of 1.01 to 1.27 with individual patient case scores of 1.00 to 46.59. Surgeons operating more than 1,500 cases had per surgeon mean scores of 1.06 to 1.26 with individual patient scores of 1.00 to 46.59.
Among the study’s other findings were that ocular comorbidity increased from about 30% of cases in 2007 to 37% in 2016, while cases with BCVA ≤ 0.1 decreased from 20% of cases to about 10%.
In addition to the case mix and complication correlations, the study found that the proportion of cases performed by surgeons doing 1,000 to 1,499 and 1,500+ cases increased significantly in recent years, to about 21% and 12% of total volume respectively in 2016.
Those doing 500-999 cases increased slightly and accounted for the biggest slice of volume at about 35% in 2016. This mid-volume group edged out in 2014 those doing 100-499 cases, which declined from a 60% market share in 2007 to about 30% in 2016.
Madeleine Zetterberg: madeleine.zetterberg@gu.se
These were all very highly associated with increased capsule complications
Madeleine Zetterberg MD, PhD
The difference was not all that great, though. The high-volume surgeons are still doing a lot of complicated cases
Madeleine Zetterberg MD, PhDMadeleine Zetterberg
MD, PhD
In times of great trials, Eric D Donnenfeld MD reflects on the words of Admiral James Stockdale, who spent seven years as the most senior US Naval officer in a North Vietnamese prison camp and received the USA’s Medal of Honor for his leadership.
“You must never confuse faith that you will prevail in the end – which you cannot afford to lose – with the discipline to confront the most brutal facts of your current reality, whatever they might be.”
Such is the essence of leadership required of ophthalmologists returning to practice in the face of COVID-19, said Dr Donnenfeld, of New York University, at the ASCRS Virtual Annual Meeting 2020. “We must care for our patients, we must preserve and improve vision, and we must do no harm.”
That means not only providing technologically advanced eyecare. It also means straightforwardly addressing new realities, such as enhanced infection control, virtual medicine, and financial and management stress, required to provide patients with the safety they expect and deserve.
“Hope is on the way. I look forward to a new dawn in managing ophthalmic care,” said Dr Donnenfeld, who co-chaired two symposia on reopening practices after one-to-three months away due to the COVID-19 pandemic.
The job of a practice leader is three-fold, said Bruce Maller, founder and CEO of BSM Consulting, based in Incline Village, Nevada, USA, and specialising in healthcare practice management: protect the integrity of your business; responsibly manage your team to the other side; and stay connected with patients, colleagues and strategic partners. That means ensuring practice finances and business arrangements are preserved as much as possible while doing right by employees and others critical to reopening.
Mr Maller identified several important qualities of a successful leader. Stay calm at
all times. Educate yourself on the challenges – and opportunities – you face. Act the part – what you do and say and how you say it affects other people. Be decisive; this is not time for paralysis by analysis. Be selfless; many are leading the way by cutting their own salaries to help employees.
Effective leadership also requires hope to inspire yourself and your team, Mr Maller said. “We got this. I’m confident we as a team can appropriately manage our way.” Be clear and concise in your communication, including business essentials such as how much cash the practice has and how it is being used. And always demonstrate empathy for the trials of others.
Cultivating courage and confidence among staff and patients is a critical leadership skill for emerging from the current crisis, said psychologist Craig Piso PhD, president of ophthalmology management consultants Piso and Associates, based in Larksville, Pennsylvania, USA. “The linchpin question is will people feel safe enough to re-engage in their previous roles.”
The answer comes in two steps. First, practice leaders must find within themselves the courage and strength to face the deadly virus itself as well as all the physical, financial and psychological challenges that come with it. Second, leaders must provide influential leadership that instils that courage and strength in patients and staff.
“Courage is not the absence of fear, it is taking deliberate, effective action even when
your knees are shaking,” Dr Piso said. He recommended stoicism as a philosophy and a practice to gain internal courage. It entails shifting focus from external circumstances over which we have no control, to managing internal thoughts, beliefs and expectations.
The resulting internal victories in managing attitudes, emotions and exercising personal will pay off in enhanced tranquillity, fearlessness and freedom in the face of adversity, Dr Piso said. “This will exude a vibe that helps your people.”
Dr Piso also referenced what he called the Stockdale paradox as a touchstone for crisis leadership. Through years of torture “he maintained an unwavering sense that he would prevail in the end, details to follow, not knowing when or what would happen, but believing in the end that victory was his to have”.
For the public victory, shift from “I” to “We,” engage staff in developing a detailed action plan and empower people with information, Dr Piso said. “Inspire loyalty and followership.”
Leadership also means taking the opportunity to re-evaluate professional and personal goals, said John P Berdahl MD, of Sioux Falls, South Dakota, USA. It took a pandemic to bring home first principles.
Just as in the military where officers eat after their troops, “we need to put our team and those that are most vulnerable first”, Dr Berdahl said. He also realised the rules of the game of life and practice are shifting rapidly, requiring constant attention and more-adaptable responses. “The goal is to keep playing and keep playing better.”
On a more personal level, the pandemic has given Dr Berdahl time to build a nonophthalmology dimension to his life. “Life has slowed down enough that we can seek out whatever it is to be a normal family.”
That includes getting a puppy, learning guitar and walking an hour a day with his wife, which has become a powerful grounding force in Dr Berdahl’s life. “Working 20% less for 30% less pay is probably a good trade.”
We must care for our patients, we must preserve and improve vision, and we must do no harm
Eric D Donnenfeld MD
An ongoing clinical trial of Holoclar, the first stem cell therapy approved by the European Medicines Agency (EMA), continues to demonstrate the effectiveness of transplants of cells cultured and expanded ex vivo for treating limbal stem cell deficiency (LSCD) due to chemical burns and other injuries, Graziella Pellegrini told the 37th Congress of the ESCRS in Paris, France.
Prof Pellegrini presented the cases of two typical Holoclar patients from the current study, which involves 19 sites in eight European countries. One year after treatment, one adult and one child each recovered 9/10 best-corrected visual acuity and clear corneas from counting fingers and hand waving, respectively, due to complete coverage of the cornea by conjunctival tissue. These results are largely consistent with an earlier study showing stable, clear corneas for patients for as long as 10 years after treatment, with 76.6% achieving permanent corneal restoration (Rama P et al. N Engl J Med 2010; 363:147-155).
The current open-label prospective trial, scheduled to conclude in late 2021, is required by the EMA to generate additional clinical data on Holoclar following its conditional approval in 2015. It is part of a broader data collection effort including sites across the continent and UK using the treatment commercially that is necessary to bring personalised and genetic treatments to the clinic, said Prof Pellegrini, who has written extensively on the challenges of translational advanced medicines (Attico E et al. Curr Transplant Rep. 2018; 5(3): 244–250. Pellegrini G et al. Stem Cells Transl Med. 2018;7(1):146–154).
Because autologous treatments such as Holoclar use autologous cells from individual patients as raw materials, their contents are by definition far more diverse than in traditional medicines. This makes it difficult to apply the same kind of industrial process and increases quality controls usually required for regulatory approval – a significant hurdle to approval and commercialisation of stem cell and genetic therapies and a major reason for the extensive post-approval research EMA requires.
Prof Pellegrini described the process by which Holoclar is produced as well as some of the quality checks required to ensure its safety and efficacy. It involves harvesting few stem cells from a spared area in one of the two eyes, so patients who have complete loss of stem cells in both eyes are not candidates.
These harvested cells are cultured and expanded, and frozen as the raw material to produce one or more batches of the drug as required. Cells are thawed as drug substance, then cultured on a carrier from which a graft for transplant is constructed. The graft must be transplanted within 36 hours, and must be carefully handled within strict temperature limits in transport. Should the first graft fail a second can be produced, often from the original cell culture.
Control samples are obtained and examined at the end of each phase of the process to monitor variability and select appropriate cell cultures to proceed, Prof Pellegrini noted. Tests can reveal cell abnormalities, or symmetric vs asymmetric division. The holoclone cells essential to the restoration process also can be identified by their level of p63 protein expression, and these must exceed 2.5% of the cultured cells to ensure efficacy. Post-transplant histology monitored in vivo integration of the transplanted tissues on the cornea, revealing restoration of normal corneal physiology over time.
Prof Pellegrini also presented an update on a genetically modified stem cell treatment in development targeting a hereditary cause of LSCD, in the last treated case a lifethreatening variant of junctional epidermolysis bullosa (JEB) that also produced burn-like lesions over 70% of the young patient’s body. Histological analysis found the genetically modified transplanted autologous stem cells integrated across the child’s epidermis over time. The result is a complete regeneration of the skin, and a return from near death in a burn unit to normal life 3 months after treatment (Hirsch T et al. Nature. 2017; 10.1038/ nature24487) and up to three-to-five years.
“This shows we can provide personalised medicine by genetic correction,” said Prof Pellegrini, of the Centre for Regenerative Medicine Stefano Ferrari, University of Modena and Reggio Emilia, Modena, Italy.

Prompt, early diagnosis, tailored treatment and careful monitoring are the cornerstones of optimal management of neurotrophic keratopathy (NK), according to Leonardo Mastropasqua MD, Italy.
Speaking during a dedicated session on non-healing corneal-ulcers during the 37th Congress of the ESCRS in Paris, France, he outlined the hierarchy of medical treatment for NK, from lubricant to matrix therapy, and nerve growth factor (NGF) and stressed the importance of accurate diagnosis and staging.
Dr Mastropasqua noted that the key goals in the treatment of NK are to promote healing, avoid worsening, reduce recurrences and preserve vision.
“Thus the early diagnosis, severitybased treatment and monitoring of the eye is mandatory to achieve epithelial healing and prevent stromal lysis and perforation,” he commented.
It is also “very important to treat the environment contributing to dry eye, specifically inflammation”, he added.
Dr Mastropasqua advocated taking a step-ladder management approach according to NK stage/severity to stop progression and reverse NK changes (as per the Dua et al 2018 consensus paper), which comprises three steps involving medical management, followed by nonsurgical intervention, followed by surgical management.
In mild stage 1 cases of NK
where there are epithelial changes without epithelial defects the aim is to improve epithelial quality and transparency; stabilise epithelium and avoid epithelial breakdown; and prevent progression to moderate stage (persistent epithelial defect), he said.
Therapeutic options at this stage include non-preserved topical medications, tear substitution, treating concurrent ocular surface disorders, anti-inflammatory therapy, therapeutic contact lenses and, if needed, punctal occlusion and debridment of sick epithelium.
“But if we have concurrent inflammation it is very important to find out if it is infection and identify pathogens and treat them,” Dr Mastropasqua said, adding that if there is a negative culture finding he would give oral azithromycin or other broad spectrum topical antibiotics, but advised against using toxic aminoglycosides like gentamicin. “The aim is to minimise ocular irritants and reduce inflammation,” he reminded delegates, adding that “eyelid hygiene is of course important”.
Dr Mastropasqua urged caution if using steroids and said topical non-steroidal inflammatory drugs (NSAIDs) should be totally avoided, but topical ciclosporin is also an option.
Successful tear substitution should reduce mechanical epithelial damage and dilute pro-inflammatory mediators with good options available, he added.
Moving on to moderate stage 2 NK where there is a persistent epithelial defect, intervention should aim to promote epithelial healing, prevent the recurrence of epithelial breakdown and prevent progression to severe stage (stromal lysis), Dr Mastropasqua explained.
For these patients, therapeutic options include topical preservative-free antibiotics, tetracycline/macrolides to prevent stromal melting, biological medical products, serum eye drops and platelet-rich plasma, therapeutic contact lenses, non-surgical eyelid closure and, if these options fail, a surgical approach of tarsorrhaphy-amniotic membrane transplantation-conjunctival flap can be performed, he outlined.
Dr Mastropasqua also discussed topical regenerating agents explaining that they
are biopolymers engineered to mimic the structural and functional properties of heparan sulfates, which work by the creation of a cellular microenvironment favourable to corneal healing. They offer protection against extensive proteolysis induced by inflammatory, necrotic or fibrotic processes.
Finally, looking at interventions for severe stage 3 NK, Dr Mastropasqua said the aim here again is to promote corneal healing and prevent further corneal stromal lysis and perforation.
He discussed the rise of topical treatment with NGF agents for corneal neurotropic ulcers, quoting early research from 1998 and more recent trial data on the use of recombinant human NGF (rhNGF) for NK. He said the latest multicentre findings show that rhNGF was well tolerated in patients with stage 2 or 3 NK. “So favourable trends in corneal healing suggest that rhNGF may be effective for treating moderate to severe NK”.
Summarising his presentation, Dr Mastropasqua said his take-home message was that severity-based treatment based on accurate staging of NK is key: “Prompt treatment improves success rates, prognosis and vision.”
Concluding he said that the use of rhNGF “is an aetiological treatment that may change of the prognosis of NK evolution”.
But if we have concurrent inflammation it is very important to find out if it is infection and identify pathogens and treat them
Leonardo Mastropasqua MD
...severity-based treatment and monitoring of the eye is mandatory to achieve epithelial healing and prevent stromal lysis and perforation
Leonardo Mastropasqua MD
Molecular-scale particles hold promise in new treatments for visual correction. Howard Larkin reports
The multiple lipid, aqueous, mucin and lysozyme-rich layers of the tear film and cornea are highly effective at keeping irritants and pathogens out of the eye. The trouble is, they are nearly as effective at keeping out topical drugs – only 5-to-10% administered typically reach the anterior chamber, David Smadja MD told the 37th Congress of the ESCRS in Paris, France.
Similarly, the sclera blocks topical drugs from the retina and vitreous while the blood-retinal and retinal pigment epithelium barriers restrict systemic drugs. That leaves invasive injections and intravitreal depots as the most effective administration routes for back-of-the-eye treatments, and these are subject to rapid chemical breakdown, added Dr Smadja, who directs and conducts research at Shaare Zedek Medical Centre, Jerusalem, and Bar-Ilan University, Ramat Gan, Israel.
Nanotechnology could change that, Dr Smadja believes. Nanosystems measuring 300nm or less – about three times the diameter of the HIV virus – may overcome problems that reduce drug efficiency by combining and layering even smaller nanoparticles – of 1-to-100nm – with varying chemical, electrical, biologic and physical characteristics. Together, these may be designed to address major challenges in anterior and posterior drug delivery, including drug washout, lack of penetration and enzymatic destruction.
Adding positively charged mucoadhesive particles, such as chitosan, to the surface of a nanocapsule could greatly increase residence time in the precorneal space by sticking to the negatively charged posterior layer of tear film (mucine layer), Dr Smadja said. This allows more time for smaller drug particles in the capsule to penetrate the corneal epithelium, reducing washout. Residence time could be further enhanced by placing nanocapsules in a hydrogel matrix or contact lens placed on the ocular surface.
On the corneal surface, nanocapsules could slowly release even smaller capsules coated with lipophilic material designed to move hydrophilic drugs through the lipid-rich epithelium and endothelium. Materials such as hyaluronic acid-chitosan nanoparticles have successfully penetrated cell barriers.
“It’s the old trick we all know, the Trojan horse, where you encapsulate the drug in something that looks friendly,” Dr Smadja said.
Sustainability of release is a major challenge for posterior segment drugs. Particles smaller than 200nm, anionic particles, and PEGylated particles are more likely to diffuse to the retina, Dr Smadja said. Nanoparticles also can be engineered to resist longer to enzymatic degradation and slow release by surrounding drugs with compounds that resist lysozymes.
“The future of ocular drug delivery systems is bright,” he concluded.
Another innovative topic discussed was the use of nanotechnologies for correcting refractive errors. This could be achieved either by “nano-eye drops” instillation, where the nanoparticles will penetrate into the epithelium layer within a specifically designed optical pattern that will locally modify the refractive index of the cornea. Another way could be to modify the current progressive lense design into glasses by adding a nanoparticles coating that could controllable externally for adjusting focus and zoom.
The aim of the project is to build a common assessment methodology and establish an EU web-based registry and network for academics, health professionals and authorities to assess and verify the safety quality and e cacy of corneal transplantation.
Registry
www.ecctr.org
ECCTR is a project funded by the ESCRS with initial support from the EU
In an era when intravitreal anti-VEGF is the mainstay of treatment in exudative agerelated macular degeneration (AMD), vitreoretinal surgery still has a fundamental role to play in managing patients with advanced disease, according to Grazia Pertile MD, who delivered the annual Gisbert Richard lecture at the 19th EURETINA Congress in Paris, France.

“This is rescue surgery, so obviously the indications for surgery are quite limited. Surgery can be considered when anti-VEGF therapy does not achieve an adequate response and the patient continues to lose vision, or when the complications of CNV cannot be managed with intravitreal injections alone such as a tear in the retinal pigment epithelium or in the presence of subretinal haemorrhage,” she said.
She explained that two of the principal surgical options for advanced AMD include full macular translocation (FMT) and autologous choroidal transplantation.
FMT permits the relocation of the diseased macula on to an area of unaffected retinal pigment epithelial and choroid, and has been successfully used to restore the anatomy and visual function in some patients with AMD when the outer retina layers are not irreversibly damaged, noted Dr Pertile.
Vision-threatening complications after FMT surgery include cystoid macular oedema (CME) in 8% of cases, retinal detachment in 7.3%, proliferative vitreoretinopathy (PVR) in 4.2% and macular hole in 5.5%. She added that the presence of the external limiting membrane (ELM) seems to be the most reliable factor in predicting the functional outcome.
Vision-threatening complications associated with choroidal transplantation include late or no revascularisation of the graft in about 12% of cases, postoperative subretinal haemorrhage in 10%, retinal detachment with or without PVR in 4% and macular hole in 7%.
Although fast reperfusion of the
choroid is a sign of successful surgery, a delay in reperfusion may lead to retinal damage and poor outcomes.
“Early reperfusion of the graft is crucial and it usually starts at the edge of the graft and proceeds quite slowly. We found in these cases that it can useful to scrape Bruch’s membrane – the idea is that the blood vessels come from the underlying choroid and sometimes Bruch’s membrane can block this reperfusion. After scraping using a subretinal spatula we usually encountered a high rate of reperfusion,” she said.
Dr Pertile added that RPE contiguity after autologous choroidal graft also seems to be a protective factor against atrophy progression, whereas any area of damaged or absent RPE tends to enlarge over time.
She noted that the incidence of retinal detachment and proliferative vitreoretinopathy (PVR) can be reduced with careful peripheral vitrectomy and removal of cortical vitreous remnants.
It is also important to try to avoid contraction of the vitreous base by ensuring that the subretinal BSS injection is performed posterior to the equator. Likewise, performing a peripheral retinotomy close to the ora serrata helps
to reduce the risk of PVR, she added. Choroidal grafts should ideally be harvested away from large choroidal vessels outside the posterior pole to reduce the risk of postoperative subretinal haemorrhage. The risk of intraoperative bleeding can be minimised by increasing the IOP to around 70mmHg during the surgery, she said.
In trying to decide which surgical strategy to adopt, Dr Pertile said that FMT works best in patients with low best-corrected visual acuity in the fellow eye, with a subsequent risk of diplopia, as well as those with a healthy RPEchoroid area in which to relocate the macula. Choroidal graft may be considered in other cases that do fall into these particular categories.
Good functional results can be obtained over the long term with FMT, said Dr Pertile.
“We analysed 255 FMT cases in 2015 with 163 meeting the inclusion criteria and the majority of patients experienced an improvement in visual acuity. A few patients did lose vision, but the improvement for the majority of patients was maintained for up to five years after surgery. Patients with foveal RPE atrophy, CNV recurrence, and PVR carried a worse prognosis,” she concluded.
Pneumatic vitreolysis seems to be a safe and highly effective technique for treating symptomatic vitreomacular traction (VMT), once careful patient selection is respected, according to Marc Veckeneer MD.
“We have experienced excellent results with pneumatic vitreolysis in cases of focal vitreomacular traction with severe symptoms. For those patients with epiretinal membrane (ERM) or larger macular holes, vitrectomy will probably be required,” he told delegates attending the 19th EURETINA Congress in Paris, France.





Management options for VMT typically include observation, vitrectomy, intravitreal injection of ocriplasmin or pneumatic vitreolysis, noted Dr Veckeneer, Middelheim Hospital, Antwerp, Belgium.
The clinical trial results of ocriplasmin were disappointing, said Dr Veckeneer, with VMT resolution in about 26.5% of patients.
“This outcome improved in some recent ‘real-world’ studies to around 50%, but there are still some concerns with adverse events and we are not using it in our clinic at the moment.”
In the meantime, evidence on the efficacy of pneumatic traction release is accumulating. In a recent case series of 22 eyes of 19 patients treated with an injection of 0.2 cc C2F6 gas for focal vitreomacular traction with severe symptoms, Dr Veckeneer and co-authors achieved VMT release in 18 eyes (82%) within three months.

Other recent studies in the scientific literature on gas injection for VMT confirm our positive results, said Dr Veckeneer.
“These are not randomised trials, but if we look at the published data for pneumatic release and combine the patient numbers, the chances of having a VMT release by just injecting gas are very high – about 89% in 131 patients overall,” he said.
In addition, with regards to safety, the longstanding experience with the injection of a gas bubble in the vitreous cavity is vast and reassuring.
The optimal timing for intervention is not obvious, said Dr Veckeneer, noting that one-third of VMT patients will get worse, one-third will have spontaneous VMT release and one-third will remain stable throughout follow-up.
Observation is probably the best strategy for those patients with good visual acuity and no or minimal symptoms, while intervention is justified in cases of severe symptoms and visual loss. For patients with concomitant disease such as macular degeneration or diabetic macular oedema, Dr Veckeneer said that the impact of successful traction release on the underlying disease progression remains highly uncertain. Chances of a successful outcome seem higher in cases where the outer retinal and retinal pigment epithelium (RPE) degenerative changes, as seen on OCT, are still limited and in close correspondence to the area of vitreous adhesion.
“If the retinal changes are more extensive and do not correspond well with the traction, I would be very careful indeed in proceeding with surgery in these patients,” he said.
 Marc Veckeneer: veckeneer.icare@gmail.com
Marc Veckeneer: veckeneer.icare@gmail.com

Pneumatic vitreolysis safe and effective in vitreomacular traction.
Dermot McGrath reports
2–4 October 2020 3 days. 3 channels.
We are excited to bring you our first virtual conference. The 20th EURETINA Congress, scheduled to take place in Amsterdam, will instead take place as a virtual congress experience.

www.euretina.org

VOL: 243 ISSUE: 4
A meta-analysis of 29 randomised controlled trials (RCTs) and 11 real-world studies shows that the improvements in BCVA diabetic macular oedema (DME) patients achieve over three years of treatment with ranibizumab correlates strongly with the number of the injections they receive. The analysis showed an increase in BCVA of 8.2, 9.4 and 10.3 ETDRS from baseline following 12, 24 and 36 months, respectively, of ranibizumab treatment. The largest changes in BCVA at 12 months were observed in RCTs and the smallest in real-world studies. In addition, an increase of one injection was associated with an increase in BCVA of 0.6 letters at 12 months. M Falcão et al “Impact of Intravitreal Ranibizumab Therapy on Vision Outcomes in Diabetic Macular Edema Patients: A Meta-Analysis”, Ophthalmologica 2020, Volume 243, issue 4.


Evaluation of retinal microcirculation with optical coherence tomography angiography (OCT-A) can detect early changes related to nephropathy in type 2 diabetic patients, a new study indicates. It showed that, compared with 42 normoalbuminuric diabetic patients without retinopathy and 55 controls , 42 diabetic patients with microalbuminuria had significantly decreased mean vessel densities of the superficial capillary plexus (SCP), whole disc, and peripapillary area (p<0.05 for all). Both duration of diabetes and urinary albumin levels were significantly and moderately correlated with mean vessel density of whole SCP in diabetic patients. V Cankurtaran et. al. “Retinal Microcirculation in Predicting Diabetic Nephropathy in Type 2 Diabetic Patients without Retinopathy”, Ophthalmologica 2020, Volume 243, issue 4.
A new study’s findings indicate that 25-gauge endo-illuminationaided scleral buckling (SB) combined with hyaluronate injection is a safe and effective treatment for rhegmatogenous retinal detachment (RRD). The retrospective study involved 45 RRD patients, 25 of whom underwent the new SB procedure, and 20 of whom underwent conventional SB with binocular indirect ophthalmoscope combined with air injection. The final reattachment rate was 100% in both groups. The improvements of BCVA of the treatment group and control group were –0.49 and –0.42 logMAR, respectively with no significant difference (p=0.594). However, the mean operation duration of the treatment group was significantly shorter than that of the control group (50.19min vs 42.06min, p=0.042).T Zhao et al, “Endo-Illumination-Aided Scleral Buckling Combined with Intravitreal Injection of Hyaluronate for Treatment of Rhegmatogenous Retinal Detachment”, Ophthalmologica 2020, Volume 243, issue 4.
The patient-reported outcome is linked to clinical data in EUREQUO. This enables better knowledge of indications for surgery and o ers a tool for clinical improvement work based on the patients’ outcome.


Amulti-faceted and proactive approach that includes deploying mobile clinics and home visits where necessary has helped to ensure that the majority of patients with retinal disease are still receiving treatment during the COVID-19 pandemic in Tel Aviv, Israel, according to Prof Anat Loewenstein MD.
Speaking during a special webinar organised by the Intravitreal Expert Group, Prof Loewenstein, Full Professor of Ophthalmology at the Sackler Faculty of Medicine at Tel Aviv University, said that her department has managed to maintain patient care despite widespread disruption caused by the virus.
“Israel took very strict measures at the beginning of the pandemic so we have been doing pretty well with quite a low mortality rate compared to some other countries. In terms of healthcare, all elective procedures were postponed and we organised the staff into separate teams so that one-third of the staff was present and working at any one time. This helped to limit the risk of infection,” she said.
From the early stages of the pandemic, Prof Loewenstein’s team contacted patients in order to identify the more urgent cases and determine the best treatment strategy for each individual patient.
“We took a few measures to try to ensure that everyone was covered. We offered telemedicine services for every patient for
whom that was compatible. We continued emergency surgeries and also intravitreal injections. We did this in three ways: by bringing patients into the clinic but with extra hygiene measures in place and visits spaced out to limit contact. We did everything as quickly as possible once they were in the clinic. Where possible, we also switched patients from PRN and treatand-extend to fixed regimens so there was no need to perform OCT,” she said.
Another strategy was to set up a remote clinic outside the hospital thanks to a donation from a private company.
“This enabled us to provide all the necessary equipment off site and to limit the contamination risk to the hospital. Once the structure was in place, the physician would go to the mobile clinic and administer the intravitreal injections there,” she said.

The most ground-breaking step, however, was to bring treatment directly to the patients at home.
“This was quite revolutionary. We all wore protective gear and treated each patient as if they were COVID-19 positive and we were able to administer dozens of injections daily in this way in the patients’ homes. We gave priority to elderly patients with limited mobility who could not come to the hospital or mobile clinic,” she said.
With the immediate crisis now over, Prof Loewenstein said that the priority now is to ensure that all patients receive treatment.
“Our ‘no show’ rate is about 25% and some of these patients risk losing vision because they are afraid to come to the hospital. In Israel there is a major media campaign to incite patients to come to the clinics for treatment and emphasising the measures that are put in place to ensure their safety. We need to be proactive, to contact the patients, reassure them and let them know that we have a safe environment for them in which to receive their injections,” she said.
Israel took very strict measures at the beginning of the pandemic so we have been doing pretty well with quite a low mortality rate
Anat Loewenstein MD

Axial elongation is the most important mechanism contributing to the development of myopic macular degeneration (MMD), with no clear evidence of molecular factors specifically associated with development of the condition, according to Gemmy Cheung FRCOphth.
“This was a small pilot study and while we clearly identified certain molecular factors associated with axial elongation, we did not identify any specific to the development of MMD,” she told delegates attending a symposium on myopia at the 19th EURETINA Congress in Paris.
Explaining the rationale behind the study, Prof Cheung, Head and Senior Consultant, Medical Retina Department, Singapore National Eye Centre, Singapore, said that it is important to differentiate pathologic myopia from high myopia.
“We know with high myopia there is axial elongation, whereas with pathologic myopia there are characteristic changes in the sclera, choroid, and retinal pigment epithelium (RPE) with compromised visual function. Previously described risk factors for MMD include severity of myopia, and other factors such as age or gender, but the question we wanted to answer is why don’t all myopic eyes with elongated axial lengths develop MMD?
“With that in mind, we carried out
this pilot study to determine if there are molecular processes specifically associated with the development of MMD in eyes that are already axially elongated,” she said.
The study team obtained aqueous humour during routine cataract surgery of 14 emmetropic control eyes, 12 eyes with high myopia without macular changes and 12 eyes with MMD. High myopia was defined as axial length greater than 26.5mm. Eyes with myopic choroidal neovascularisation at any stage were excluded. Axial length and subfoveal choroidal thickness were recorded for all eyes.
The study focused on four key molecular factors of interest, said Prof Cheung: extracellular matrix remodelling – matrix metalloproteinase 2 (MMP), tissue inhibitor of metalloproteinase (TIMP); vascularity – vascular endothelial growth factor isoform A (VEGF-A), pigment epithelium-derived factor (PEDF), and angiopoietin (Ang-2); Bruch’s membrane elongation – amphiregulin; and inflammation – interleukin (IL-6, IL-8, and C-reactive protein (CRP)).
The results showed that VEGF-A concentration in aqueous humour linearly decreased and the MMP-2 concentration linearly increased with longer axial length. However, after adjusting for axial length, none of the molecular factors were associated with MMD, said Prof Cheung.
For choroidal thickness the researchers found a correlation with MMP-2 but surprisingly no association with VEGF-A.
“The correlation between choroidal thickness and MMP-2 but not VEGF-A suggests that axial elongation rather than ischemia may be the predominant underlying mechanism leading to choroidal thinning. So this pilot study suggests that it may be more mechanical stretching rather than primarily ischemic phenomena at work here,” she concluded.
Gemmy Cheung: gemmy.cheung.c.m@singhealth.com.sg
«Hard cataracts are easy to deal with and the anterior chamber is stable. You can notice this especially in patients with floppy iris syndrome. The iris remains calm.»
Daniel Bruun MD Switzerland
The question we wanted to answer is why don’t all myopic eyes with elongated axial lengths develop MMD?
Gemmy Cheung FRCOphth
As minimally invasive glaucoma surgery (MIGS) devices proliferate, including several stents for augmenting Schlemm’s canal or routing aqueous outflow to the supraciliary or subconjunctival space already on or near the market, it may seem like too much to choose from. Yet given the diversity of patient needs and the pluses and minuses of each approach, there’s no such thing as too many MIGS options, Norbert Pfeiffer MD told ESCRS Glaucoma Day 2019 in Paris, France.
Dr Pfeiffer, of Johannes Gutenberg University, Mainz, Germany, characterised MIGS devices as those delivered via paracentesis using an “ab interno” approach that leaves the conjunctiva untouched, or nearly so. He reviewed three categories of MIGS stents currently or soon to be available.
Stenting Schlemm’s canal is intended to increase aqueous outflow by overcoming resistance in the trabecular meshwork. Combined with phacoemulsification cataract surgery, the original iStent (Glaukos) showed moderate lowering of mean intraocular pressure (IOP) compared with phaco alone, 8.5±4.3mmHg vs
8.4±3.6mmHg, with slightly lower use of medications, 0.2 vs 0.4, with significantly more iStent patients meeting target IOP with and without medications, Dr Pfeiffer pointed out (Samuelson et al. Ophthalmology. 2011 Mar;118(3):459-67).
Dr Pfeiffer suggested the reason the stent did not lower IOP more may be its small size. “Schlemm’s canal is not a garden hose; there are outflow channels in some places but not others. If you put a stent in just one place it may not be enough.”
The Hydrus Microstent (Ivantis) is designed to address this issue by holding open three clock hours of Schlemm’s canal, ensuring multiple outflow channels are exposed.
“It is a maximally large minimally invasive stent” which is fed into the canal lengthwise, Dr Pfeiffer said.
In a study he conducted with colleagues, eyes treated with both the Microstent and cataract surgery showed washout IOP more than 2.0mmHg lower than eyes receiving cataract surgery alone at 24 and 36 months (Fea A et al. ESCRS 2018. Pfeiffer N et al. Ophthalmology. 2015 Jul;122(7):1283-93).
The second-generation iStent inject allows insertion of multiple stents and appears to reduce IOP more than a single device. All three intracanalicular devices require a bimanual approach with gonioscope in one hand to provide a good view of the angle while inserting the device with the other hand.
A second approach is the supraciliary stent, which drains aqueous into the space between the uvea and sclera, which separate easily, making them less challenging to insert than canal shunts, Dr Pfeiffer said. The CyPass Micro-Shunt (Alcon) was an early example.
When combined with cataract surgery CyPass reduced mean IOP 7.4mmHg vs 5.4mmHg for cataract surgery alone, and reduced the need for glaucoma medication dramatically compared with cataract surgery alone (Vold S et al. Ophthalmology. 2016 Oct;123(10):210312). However, the device was removed from the market due to increased loss of corneal endothelial cells five years after surgery.
The MINIject (iSTAR Medical) is a supraciliary stent now in pivotal clinical trials that has reduced IOP by nearly one-third.
“We will see what the results will be,” Dr Pfeiffer said. The potential for late side-effects must be closely monitored, he added.
Subconjunctival stents, such as the XEN (Allergan), are inserted from inside the eye, routing aqueous under the conjunctiva to form a filtration bleb much like a trabeculectomy, Dr Pfeiffer said. A clear view of the angle is required to insert the device through the sclera and under Tenon’s capsule, holding them apart to form a bleb. Potential complications include hypotony and subchoroidal bleeding.
The InnFocus MicroShunt (Santen) is not really a minimally invasive device since it is inserted from the outside under the conjunctiva, Dr Pfeiffer noted. It is often inserted with antifibrotics to preserve the bleb. While it appears to significantly reduce IOP, establishing its safety relative to trabeculectomy will require more time and study, he added.
“Variety helps and it is good to choose from. But variety shows the search for the ideal stent is still going on,” Dr Pfeiffer concluded.
norbert.pfeiffer@unimedizin-mainz.de
Norbert Pfeiffer:
It is a maximally large minimally invasive stent which is fed into the canal lengthwise
Norbert Pfeiffer MD
Schlemm’s canal is not a garden hose; there are outflow channels in some places but not others. If you put a stent in just one place it may not be enough
Norbert Pfeiffer MD
Philip Bloom reports
In a special webinar organised by the UK and Ireland Society of Cataract and Refractive Surgeons (UKISCRS), Philip Bloom, President of UKISCRS and Chair of the International Glaucoma Association (IGA) spoke about his experience as a consultant ophthalmologist at the Western Eye Hospital and Hillingdon Hospital.
“We have been operating similarly to many other glaucoma units throughout the country. The call came to stop all elective activity, so we had to decide how we were going to manage that. The units that had already employed risk stratification were at an advantage but it helped that Moorfields Eye Hospital shared their very prescriptive system of risk stratification and the Royal College of Ophthalmologists’ guidance came out that all routine ophthalmic surgery and all face-to-face consultations should be postponed wherever possible. This is particularly appropriate as age is a major risk factor for glaucoma, and also for the most serious sequelae of COVID-19 infection. We implemented the recommendations straight away.
“I was fortunate in that both the sites that I work at use a colour-coded risk stratification system (red, amber and green for high risk, medium risk and low risk respectively) that was electronically accessible. Patients who are classed as “red” still have to be seen, whereas green patients can be postponed for anything from three-to-six months; amber patients are considered on a case-by-case basis. Fortunately, glaucoma is usually a stable and very slowly progressive disease. We are still seeing those patients that absolutely need to be seen in the A&E department and in the clinics.
“One of the difficulties has been changing advice: as of last week, we now treat every patient as if they were infected with COVID-19. This makes it simpler because we no longer have to try to determine if they are likely COVID-19 positive or not. We wear the same protective gear for everyone. Unless we are operating, we have single-use disposable gloves and gown, sessional-use fluid-resistant surgical mask and eye protection and a breath shield on the slit lamp or any similar equipment we are using. We wear scrubs in the outpatient clinic and talk as little as possible whilst within 2m of patients.
“For IOP detection we are using single-use, disposable, sterile tonometers for applanation tonometry. We avoid pneumo-tonometry (air puff, including ORA), which might be an aerosol-generating procedure (AGP), whereas we think rebound tonometry is acceptable as it probably is not an AGP. When we operate on patients, we did not initially consider phacoemulsification or vitrectomy as AGPs but the decision has now been made to do so. Similarly, in glaucoma surgery when we irrigate mitomycin C, there is a spray that comes off so we now classified all glaucoma surgery as AGPs. It is best to be cautious and err on the side of safety.
“Of course, all of this postponement of elective surgery means we will see a huge ‘bow-wave’ of demand when services start to return to normal. Considering that practically all glaucoma units were already struggling with capacity before the COVID-19 pandemic, the immediate post-COVID period will be challenging indeed for all glaucoma services.”
• ESCRS Research Portals
(Find details of ESCRSSponsored research)
• Astigmatism Double Angle Plot Tool (JCRS)
• JCRS Online Case Reports
• Landmark Articles
• ESCRS Eurotimes Podcasts
• ESCRS Player Videos
• ESCRS On Demand
• ESCRS iLearn
• EBO-ESCRS Exam and more...
Artificial intelligence (AI) has the potential to revolutionise the screening, diagnosis and classification of glaucoma in the near future, according to Xiulan Zhang MD, PhD.
“The future belongs to AI. Thanks to advanced algorithms, AI will sharply improve glaucoma diagnosis. We are making rapid progress and research is already well advanced on the development of an AI-based diagnostic and decision-making platform for glaucoma,” she told delegates attending the 37th Congress of the ESCRS in Paris.
Glaucoma diagnosis depends primarily on visual field testing and OCT evaluations, said Prof Zhang, Director of the Clinical Research Centre at Zhongshan Ophthalmic Centre (ZOC) in Zhongshan, China. She noted that it is particularly challenging for AI systems, with population differences in fundus pigmentation, disc size and cup-todisc ratio introducing potential sources of bias in the algorithms.
Much of her team’s research in recent years has been devoted to overcoming some of these challenges by building robust and diverse datasets based on thousands of visual field tests, OCT scans and fundus photographs.
The first step was to successfully develop an algorithm to differentiate glaucomatous visual field from nonglaucomatous visual field, and verify the efficacy of the algorithm in visual field classification in a multi-centre diagnostic trial after collecting more than 10,000 sample visual field tests from seven different eye centres in China.
“We assessed the performance of the algorithm with different input data in the primary validation set. Performance was still better than the glaucoma experts even though the machine-made diagnosis based on only received visual field reports,” said Prof Zhang.
Based on the study, in 2019 the team released a mobile phone and computer application called iGlaucoma 1.0 for visual field interpretation. After inputting Humphrey visual field reports or capturing printed visual field reports, the app can quickly and accurately output diagnosis, with an accuracy rate as high as 87.6%, said Prof Zhang.
“We are conducting a multi-centre clinical trial at the moment to assess the diagnostic efficacy of the algorithm in differentiation of visual field at 19 different eye centres in China. The ultimate goal is the construction of a glaucoma diagnostic and screening platform, iGlaucoma 2.0, which will combine visual field, OCT and fundus photos, and which will hopefully be available soon,”she said.
The idea is that the app can be used by non-glaucoma ophthalmologists and doctors in rural hospitals, to help them to interpret the visual field reports and improve the diagnosis of glaucoma.
Research is also continuing into algorithm development to differentiate angle width and locate the scleral spur in glaucoma patients using OCT scans. Prof Zhang said that the goal was to eventually incorporate this algorithm into a more advanced iGlaucoma 3.0 app capable of interpreting anterior and posterior segment imaging data.
Xiulan Zhang: zhangxl2@mail.sysu.edu.cn
of readers are satisfied or very satisfied with EuroTimes
80 % said EuroTimes educates them on the latest trends
83 % of readers say it's an interesting read
76 %
78% of readers trust its content
79 % EuroTimes contains up-to-date information
68% of readers prefer the printed version of EuroTimes
47,863 *

At Jordan’s sprawling Zaatari refugee camp, just a few miles from the Syrian border, 40% of the approximately 90,000 occupants are under 18 years old and 60% under 24. In a pilot study conducted by Emory University ophthalmologists, about 30% of children failed a new innovative vision screening test, with uncorrected refractive error, eye motility problems and amblyopia being the most common causes.
The scope of these issues is one reason why Atlanta, USA-based Emory University, in partnership with the Syrian American Medical Society (SAMS), made paediatric vision screening one of its top priorities for its multi-year mission in the camp. The team has thus far provided eyecare to about 16.5% of the paediatric and 7% of the adult population, Emory’s Soroosh Behshad MD, MPH, told the ORBIS International Symposium at 37th Congress of the ESCRS in Paris.
“We hope to get to 100%, but that is pretty good for the first three years,” he said.
The Emory team hope to greatly expand that figure by putting portable screening devices from Plusoptix and GoCheck Kids into the hands of specially trained staff at all SAMS clinics in the camp, under supervision of a local ophthalmologist. To address the refractive error issue, Emory hopes to install an optical dispensary at the camp to provide low-cost spectacles quickly. Working in parallel with the paediatric vision screening program, the team also has an established cataract surgery programme to help address the top cause of adult blindness in the camp.
“In having the opportunity to offer cataract surgery and glasses we can have a huge impact on reducing reversible causes of blindness with this population,” said Dr Behshad, who was once a refugee himself and whose family fled from Iran due to religious persecution.
Ophthalmic medical education rotations with two Jordanian medical schools, and mini-residency programs in a range of ophthalmic sub-specialties also have been established. The goal is to build local capacity of the host country and increase
access to subspecialty services, especially glaucoma, paediatric, and retina care – for both refugees and the host country’s population, said Emory’s Natalie Weil MD.

Yet ambitious as this project is, it barely scratches the surface of unmet refugee need. Jordan alone has 1.4 million Syrian refugees and 4.3 million refugees overall, making up 46% of the country’s population. Worldwide, there are about 70 million displaced persons, of which about 26 million are refugees living outside their home countries. They are not evenly distributed. Nearly half live in six countries that make up less than 2% of world GDP, while just 8% live in the six richest countries that make up 56% of world GDP.
Helping them, particularly in refugee camps, involves challenges that ophthalmologists must be ready to meet to succeed, Dr Weil said. One is a lack of predictability.
“There is a plan, and then there is what actually happens,” Dr Weil said.
Since camps have heavy security, clinic personnel don’t always have access when they plan to and may be sent home early. Access to equipment is also a challenge.
“You need to figure out how to be effective on the spot.”
Lack of subspecialty care is a problem, especially for glaucoma and retinal emergencies.
“In many cases, we have to find local Jordanian colleagues and partners to do many of the needed surgeries,” Dr Weil said.
Follow-up care can also be difficult because refugees are mobile and may not be in the same camp on a return visit, Dr Behshad noted.
The best way to prepare is sharpen your skills, Dr Weil said.
“You are going to see a lot of different pathology. It can be overwhelming, so be sure to prepare.” But she warned against doing procedures outside your expertise. “I don’t do anything I wouldn’t do in daily practice.”
For surgeons who cannot travel to Africa or the Middle East, Dr Weil suggests looking for refugee settlements locally.
“A lot of time you can find people who need help right in your neighbourhood.”
Saturday 26th September
The current pandemic caused by the COVID-19 virus has created upheaval in all aspects of our personal and professional lives.
We at WSPOS believe that with every challenge comes opportunity and this challenge now presents us the opportunity to deliver a new and exciting programme to a global audience via a virtual platform.

ASCRS.org is a dynamic web portal featuring a new design and enhanced features, and delivering an exceptional user experience.

The new web portal features one-touch video playback, seamless navigation across all ASCRS online platforms, and more!

Visit ASCRS.org today!
Explore hundreds of surgical videos, presentations, webinars, and more by type, topic, or meeting date Find the latest and most relevant anterior segment surgery techniques and trends by keyword, type, topic
Track your current CME credit status through real-time access to your CME transcript and certificates
ASCRS.org is your 24/7, one-stop resource for anterior segment surgical online education.
Allow me to add my entry to the long list of things that have gotten more difficult due to the coronavirus pandemic: Being a resident.
Granted, it was never an easy job to begin with. The long hours, late surgeries and weekends on call are challenging at the best of times. But at least you had ample opportunity to grow and learn as a clinician.
Fast-forward to today; Clinic numbers have been cut down in a lot of places and elective surgeries have slowed to a crawl. Meeting numbers are restricted, and not every centre has set up elearning alternatives. Conferences and exams are being cancelled, and it’s not clear whether those planned for the autumn will even be able to go ahead.
Meanwhile, the clock keeps ticking for the residents. These months without teaching are adding up. Even in a multiyear training scheme, a couple of months is a significant proportion of the teaching time.
And while we can’t change what we can’t change, we can still make efforts to preempt a shortage on training experience. Below is a curated list of some of the best (and free) educational resources out there to help you at whatever level you need.
While there are a lot of MCQ practice banks you can purchase to help you prepare for exams, the absolutely legendary Chua mrcophth.com page is always worth a visit. The appearance of this page has not changed since I was in med school but don’t let that fool you. This is a fantastic exam preparation site. Some of the clinical data may be a bit out of date but clinical signs and the volume of the available MCQs is fantastic.
If you are earlier on in your training, Tim Root — the “virtual eye professor” — hosts a library of clinical examination video lectures on timroot.com. The optics and retinoscopy sections are particularly useful for first year residency exams.
Most societies have stores of educational materials, and often provide free membership to trainees. ESCRS and Euretina are both free for three years of training and have eLearning platforms and on-demand videos of previous conferences presentations.
With a little bit more time on your hands, you may be expected to finish that research article or case report that your consultant or supervisor has been bugging you about. But how? There is nothing more intimidating than an empty page. Thankfully,
Hoogenboom and Manske are here to help. In their excellent paper “How to write a scientific article”, they offer practical tips and guidelines to target your efforts — and it’s open access.
Once your basic text is completed, try to refine it to make it a really excellent paper. Veronice Gerwin on Nature.com picked the brains of six research experts and presented them in a great article called “How to write a first-class paper”.

There has been a huge spike in the availability of high-quality teaching webinars since the beginning of the lockdown. How do you find them? Look on social media — LinkedIn, Twitter, or Facebook — and you should be able to find an interesting offer. They are usually run at about 7 or 8pm so you can relax and have a glass of wine in the comfort of your own home while you learn.
Of course, Youtube and Eyetube have a lot of videos available. The Moran eye centre (https://morancore.utah.edu/) from the University of Utah has an incredible library of presentations and surgeries on their MoranCore youtube channel. There are currently 977 videos stored there. The resident lectures in particular are great to watch.
If you are still looking for more, there are two podcasts in the field that you might want to check out. The Eyes for Ears podcast (www.eyes4ears.com) is run by two ophthalmologists, Ben Young and Andrew Pouw, who met during their ophthalmology residencies in Yale. Their episodes cover a lot, from retinopathies to aniridia, and are perfect listening for a commute to work. For the posterior segment specialists, the retina podcast “Straight from the cutter’s mouth” is already up to episode 236 and covers not only medical and surgical retina but also provides a lot of advice about career and practice development.
My final tip is a free ebook called Diabetic Retinopathy for the Comprehensive Ophthalmologist, available at drcobook.com. This book might be the most informative and hilarious take on managing diabetic retina patients. The jokes make the text light and fun for a topic that can sometimes be really taxing. With chapter titles like “Just How Often Do You Have to Drag Them Back, Anyway?” this book is as readable as it is useful.
Sorcha Ní Dhubhghaill MB PhD MRCSI(Ophth) FEBO is an Anterior Segment Ophthalmic Surgeon at the Netherlands Institute for Innovative Ocular Surgery (NIIOS) and Antwerp University Hospital


Residents face a tougher time in their training career than ever before due to COVID-19. Sorcha
And while we can’t change what we can’t change, we can still make efforts to pre-empt a shortage on training experienceIllustration by Eoin Coveney
BAUSCH + LOMB has announced the launch of a new platform of preloaded intraocular lenses LUXSMART™ AND LUXGOOD™, which feature preloaded delivery systems and Pure Refractive Optics (PRO) Technology.

LuxSmart™ and LuxGood™ comprise a hydrophobic material and represent the launch of a new platform for Bausch + Lomb, forming part of a complete range of innovative IOLs. A toric version using the same platform will also become available, in addition to the monofocal and PC-IOLs, according to the company.
“With the introduction of LuxSmart™, we are happy to access the presbyopia market with truly innovative premium IOL designs, avoiding the usual dysphotopsic phenomena that can compromise patient vision with typical diffractive optics” said Luc Bonnefoy Vice President Surgical International, Bausch + Lomb. “The Pure Refractive Optics Technology (PRO Technology) represents a great opportunity for patients to experience the benefits of presbyopia-correcting IOLs, but without the discomfort of dysphotopsic symptoms,” said Laura Pérez, Cataract & High-Tech Marketing Manager International, Bausch + Lomb. https://www.bauschsurgical.eu/
ZEISS have established a partnership with microbiome analytics firm Perseus Biomics. The partnership aims to develop an optical technology for microbiome research, specifically the quantitative analysis of the microbiome.
“The microbiome is a field of strong research interest with the potential to fundamentally change our understanding of living systems. Abundance analysis of the microbiome is one key element of this research and Perseus’ innovative optical technology has the potential to enable it at a new level,” said Gerrit Schulte, Head of ZEISS Ventures.
“We have assembled a first-class scientific and R&D team that aims to revolutionise microbiome analysis, making it faster, more precise and more affordable, while opening the way for broad-reach personalised medicine,” said Walid N. Hanna, Executive Chairman of Perseus. https://www.zeiss.com/
AbbVie (NYSE: ABBV), a research-based global biopharmaceutical company, has completed its acquisition of Allergan plc following receipt of regulatory approval from all government authorities required by the transaction agreement and approval by the Irish High Court.
“We are pleased to reach this important milestone for the Company, its employees, shareholders and the patients we serve,” said Richard A. Gonzalez, chairman and chief executive officer, AbbVie. “Our new Allergan colleagues should be commended for all their efforts, along with those of our own employees, to achieve this turning point. The new AbbVie will be a well-diversified leader in many important therapeutic categories, with both on-market and pipeline assets, and our financial strength will allow us to continue to invest in innovative science and continue to serve unmet medical needs of patients that rely upon us.”
https://news.abbvie.com/
Johnson & Johnson Vision has appointed Erin McEachren as Regional Vice President for Johnson & Johnson Surgical Vision, EMEA.
“Erin is an exceptional leader with a strong track record of success and a depth and breadth of experience. Her addition to the global Surgical Vision Leadership Team strengthens our position at the highest level of our organisation,” said Warren Foust, Worldwide President, Surgical Vision. https://www.jjvision.com/
VSY Biotechnology GmbH has announced that a new drug named TR-C 19 has been developed to treat COVID-19 by the company’s research centre.
Studies have shown that TR-C 19 can neutralise the virus isolated under laboratory conditions, according to VSY. The drug is now at the authority approval stage for usage on voluntary COVID-19 patients and clinical trial.
“[This] is one of the most meaningful projects that we have been developing,” said Dr Ercan Varlibas, Chairman of the Board of Directors of VSY Biotechnology GmbH. https://www.vsybiotechnology.com/
Professor John M. Nolan, from the Nutrition Research Centre Ireland, School of Health Science, Waterford Institute of Technology, Ireland, has received the Xtreme Research Award 2020 from Heidelberg Engineering for his research related to macular pigment for vision health and function.
Prof Nolan said: “Science is only as good as its measurements, and thankfully we now have access to gold standard technology such as the Heidelberg Engineering SPECTRALIS.
“The future of our research and its successful translation and benefits to eyecare will be driven by this innovative technology.”
https://www.heidelbergengineering.com/
One of the biggest challenges in re-opening an ophthalmic practice in the era of COVID-19 is that it is impossible to tell who has the disease. So, the only safe course is “assume every patient has coronavirus for the time-being”, said noted infectious disease specialist Matthew McCarthy MD of Weill Cornell Medical Center in New York City, USA. Speaking at the ASCRS Virtual Annual Meeting 2020, Dr McCarthy, who has treated more than 300 COVID-19 patients, advised taking universal infection control precautions in the office and surgery centre.
While a lot of general COVID-19 infection control information is available from government authorities such as the USA’s CDC and CMS, ophthalmic practice poses some unique challenges, such as clinicians spending several minutes in close proximity to patients’ faces during exams. ASCRS’ cornea clinical chair and noted ophthalmic infectious disease expert Francis S Mah MD, of Scripps Health, La Jolla, California, USA, outlined several steps ophthalmologists can take. The goal is to protect patients, staff and themselves while projecting confidence in a safe work environment, and delivering high-quality eye care.
While there has been a lot of debate about wearing face masks and face coverings, the latest research finds it is critical for controlling the spread of COVID-19, Dr Mah said. He highlighted one paper suggesting that 100% community compliance in wearing masks of moderate to high filtering efficacy would substantially halt the spread (Tian L et al. Calibrated Intervention and Containment of the COVID-19 Pandemic. 2020, https:// arxiv.org/abs/2003.07353).
So, who should wear what mask? The short answer is all healthcare professionals and staff should wear a surgical-type mask at all times, and patients should be required to wear surgical masks, cloth masks or face coverings as well, Dr Mah said. “Any face covering at all is better than no face covering.”
N95 masks, which filter out 95% of
particles 0.3 microns or larger, are among the most effective, and are appropriate for professionals to wear during surgical procedures in areas with high COVID19 incidence, Dr Mah said. However, he warned against using masks with valves that release exhaled air. These are designed for industrial use and do not guard as well against the wearer spreading disease, which is the whole point. “My mask protects you and your mask protects me.”
Dr McCarthy noted that N95 masks mostly are needed to protect personnel from aerosols created in procedures such as intubating patients. In clinic, he himself normally uses a surgical mask with an eye shield. However, since ophthalmologists spend so much time so close to patients’ faces, he suggested using an N95 mask for slit-lamp exams and procedures is not unreasonable.
Minimising direct contact and ensuring appropriate social distance among patients, staff and clinicians is another critical infection control element that touches many aspects of practice design, organisation and workflow.
To protect staff from unnecessary exposure, Dr Mah suggested dividing them into separate teams where possible. For example, billing and insurance staff might be isolated from front-desk employees. All staff meetings when needed can be conducted by telephone or video conference.
To minimise patient exposure in the office, Dr Mah suggested adopting alternative check-in processes. Screening for COVID-19 symptoms or exposure and triage of whether patients need to be seen in person can be done by telephone, as can registration and insurance checks. In the office, protective screens should be installed in front of counters, and any paperwork or payments handled by staff wearing medical masks and gloves.
To avoid patients congregating in the waiting area, Dr Mah suggested having them wait in their cars for a call or text, or escorting patients from waiting cars at
their appointment time, though this is not possible in all areas. Inside, chairs should be spaced appropriately and floors marked where patients should stand. High-risk surfaces such as magazines, brochures, coffee, water and toys should be removed.
In the clinic, workstations should be spaced two metres apart and shared workstations and phones eliminated. All equipment and surfaces should be disinfected in each room after each patient. Current USA CDC guidance calls for diluted bleach or 70% alcohol solution or Clorox or Lysol products for general disinfection. Follow manufacturer recommendations for cleaning delicate instruments, Dr Mah said.
Signage on what to do if you are sick or experience COVID symptoms should be placed at the practice entrance and check-in areas. Staff reminders to practice distancing and appropriate hand hygiene should be prominent.
Finally, take a weekly walk around your office or surgery centre to identify any need for physical modifications. Invite staff and physicians to offer feedback and suggestions, Dr Mah said. “We as eyecare specialists need a commitment to adopting protocols to prevent the transmission of the disease to healthcare personnel and patients.”
Doctors must assume every patient has coronavirus for the time-being. Howard Larkin reports
In the clinic, workstations should be spaced two metres apart and shared workstations and phones eliminated
Francis S Mah MD
Iread the other day of a travel writer turning his travel photos into jigsaw puzzles – not a bad metaphor for the times we are going through. ‘Normally’ at this time I’d be getting ready to head for Barcelona to preview next year’s ESCRS meeting, but COVID-19 and ‘cocooning’ has made us all think again about ‘normal’.
For eye surgeons the challenge is multifaceted as they adjust to ‘virtual meetings’ such as the one taking the place of the Amsterdam Congress; for a cocooned travel writer. the most obvious dilemma is finding other ways of getting through until it’s safe to pack the travel bag and head for the airport.
Here in Dublin, following the Irish Government’s guidelines, I’m ‘cocooning’. The term was invented in the 1980s by USA trend-spotter Faith Popcorn. Ms Popcorn (she legally changed her name from Plotkin) is and was considered the Nostradamus of marketing. Among her brain storms, she advised Coca-Cola to bottle water and Kodak to move to digital printing. As for ‘cocooning’, she defined it
as “the impulse to stay inside, turning the home into a nest, when the outside is tough and scary”.
She didn’t, as far as I know, predict COVID-19 or foresee cocooning as a strategy for defeating it, but here it is and here we are. Or at least here I am, cocooning, as we ‘seniors’ have been advised to do.
As a writer, I don’t have a problem filling in the time. I used the early days to organise a new book of poetry, which was published last month (Sky Full of Clouds). I don’t find lockdown/cocooning all bad, either. For me, the most positive feature of cocooning is the silence. There are no planes flying in to land at nearby Dublin airport, no traffic noises on the lane where I live. I can hear the birds – It’s been so long since I’ve heard them, I’d almost forgotten they exist. And they certainly do exist, in greater numbers for some reason. Or maybe I just have more time to notice them.
If silence is the best feature, paradoxically it is also the worst. I miss hearing the doorbell announce a friend just stopping in for coffee and a chat. I miss the chat too. But my circle of friends keeps in touch by phone, text and
email. And it’s not as if this is going to last forever. It’s not unrealistic to expect that at this time next year we’ll be back to our familiar schedules.
We’re at a point now where we can consider what we will do when the lid comes off; the chrysalis is cracking and we butterflies will soon emerge. Will it be a dinner in a good restaurant, a shopping spree or just coffee at a cafe table? In many ways, the end of cocooning will seem like New Year’s Eve: a time for celebrating the end of the old; the start of the new – reflecting on ‘auld lang syne’; and making resolutions. Among them may well be new ways to protect health at work, when travelling and at home. Appreciating what we have while we have it will surely be another.
Unexpectedly, I’ve enjoyed these last few weeks within my own walls and I’m not pushed to leave them. I expect, however, that at the first overhead roar of an airplane I’ll be hauling out my rolly bag and booking a ticket to Barcelona with the 39th ESCRS meeting in mind. See you there.
Due to the COVID-19 virus, a number of meetings have been cancelled or rescheduled. The information in this calendar is correct at the time of going to print; please check the meeting website or email the conference organisers to confirm all meeting dates.
SEPTEMBER
SFO 2020 Congress
Virtual Meeting
5 – 6 September
https://www.sfo.asso.fr/
OAS 34th Annual Scientific Meeting
Virtual Meeting
11 – 13 September
www.eyeanesthesia.org/
11th EuCornea Congress
Virtual Meeting
26 September
www.eucornea.org

WSPOS World Wide Connect 2020 Virtual Meeting
26 September www.wspos.org
OCTOBER
38th Congress of the ESCRS Virtual Meeting
2 – 4 October www.escrs.org
20th Euretina Congress Virtual Meeting
2 – 4 October
www.euretina.org
NOVEMBER
BEAVRS 2020 Virtual Meeting
6 November
https://beavrs.org/
AAO 2020
Virtual Meeting
13 – 15 November
https://www.aao.org
/annual-meeting
100th SOI National Congress
25 – 28 November
Rome, Italy
https://www.congressisoi.com
XXI International Congress of the Brazilian Society of Ophthalmology
26–28 November
Rio de Janeiro, Brazil
https://sistemacenacon.com.br/site/ sbo2020/mensagem
14th EGS Congress
14 – 16 December
Brussels, Belgium www.egs2020.org/
JANUARY
6th Annual Congress on Controversies in Ophthalmology: Asia-Australia (COPHy AA)
29 – 30 January
Bangkok, Thailand http://cophyaa.comtecmed.com/
FEBRUARY
25th ESCRS Winter Meeting
19 – 21 February
Krakow, Poland www.escrs.org
FEBRUARY
21st EURETINA Winter Meeting
26 – 27 February
Vilnius, Lithuania www.euretina.org
MARCH
6th San Raffaele OCT & Retina Forum
5 – 6 March
Milan, Italy
https://www.octforum2021.eu/
12th Annual Congress on Controversies in Ophthalmology: Europe (COPHy EU)
18 – 20 March
Lisbon, Portugal http://cophy.comtecmed.com/
JUNE
AECOS 2021 European Symposium
3 – 6 June
Florence, Italy https://aecosurgery.org/ 2021-european-symposium/

46th Meeting of the European Paediatric Ophthalmological Society (EPOS)
17 –19 June
Copenhagen, Denmark https://epos2021.dk/
JULY
AECOS 2021 Summer Symposium
15 – 18 July Utah, USA https://aecosurgery.org/ 2020-summer-symposium/
JULY
33rd APACRS–SNEC
30th Anniversary Joint Meeting
29 – 31 July
Suntec City, Singapore https://apacrs-snec2020.org/
SEPTEMBER
5th International Glaucoma Symposium
3 – 4 September Mainz, Germany https://glaucoma-mainz.de/
49th ECLSO Conference
3 – 4 September Paris, France https://www.eclso.eu/
• Reduced Registration Fees for ESCRS Congresses

• Subscription to Journal of Cataract & Refractive Surgery
• Access to ESCRS Grants, Bursaries and Research Awards
Access to:
• ESCRS iLearn Online CME accredited interactive courses
• ESCRS On Demand
Online library of presentations from ESCRS Congresses
• EUREQUO
European Registry of Quality Outcomes for Cataract and Refractive Surgery
• ECCTR
European Cornea and Cell Transplantation Registry
Join today. www.escrs.org
Join us for an exciting 3 day meeting broadcast live from Amsterdam Expert speakers, chairpersons and panellists will deliver a programme covering a range of hot topics and including lively face-to-face discussion and debate. Connect with colleagues, engage with educational opportunities and access the latest scientific data in results.
Main Symposia:
ESCRS/EuCornea Symposium: Dealing with the Traumatized Cornea
ESCRS/EURETINA Symposium: Cataract Surgery in Patients with AMD
20/20 in 2020: The Lens
20/20 in 2020: The Cornea
The Next Decade of Cataract Surgery
What to Do When the Unexpected Happens
2-4 October 2020 www.escrs.org
Programme Highlights:
Clinical Research Symposia
Video Symposia
Ridley Medal Lecture
Heritage Lecture
Covid-19 Sessions
Free Paper Forum
Poster Village
Instructional Courses
Satellite Meetings
The meeting will include:
∆ Compared to IOL Master 7001-4, IOL Master 5002-4, Lenstar LS9002. *Compared to VERION™ Reference Unit and VERION™ Vision Planner. ^ Argos biometer has shown better acquisition rates in dense cataract compared to IOL Master 7001, IOL Master 500 and Lenstar LS9002. Argos biometer has shown better predictive accuracy in medium-long eyes than IOL Master 5007,8
1. Tamaoki A, Kojima T, Hasegawa A, et al. Clinical evaluation of a new swept-source optical coherence biometer that uses individual refractive indices to measure axial length in cataract patients. Ophthalmic Res 2019;19:1-13. 2. Shammas HJ, Ortiz S, Shammas MC, Kim SH, Chong C. Biometry measurements using a new large-coherence-length swept-source optical coherence tomographer. J Cataract Refract Surg 2016;42:50-61. 3. Hussaindeen JR, Mariam EG, Arunachalam S, et al. Comparison of axial length using a new swept-source optical coherence tomography-based biometer. PLOS ONE. December 2018. 4. ZEISS† IOLMaster † 700 510k Submission 2015. 5. VERION™ Reference Unit User Manual 2019. 6. ARGOS® Biometer User Manual 2019. 7. Whang W, Yoo Y, Kang M, Joo C. Predictive accuracy of partial coherence interferometry and swept-source optical coherence tomography for intraocular lens power calculation. Sci Rep. 2018;8(1):13732. 8. Shammas HJ. Accuracy of IOL power formulas with true axial length versus simulated axial length measurement in 318 eyes using an OCT biometer. 2019 ASCRS ASOA Annual Meeting. May 2019.
